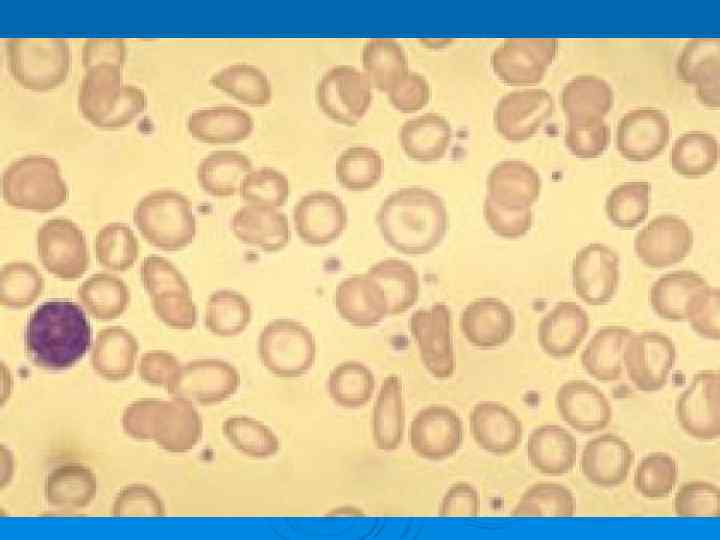
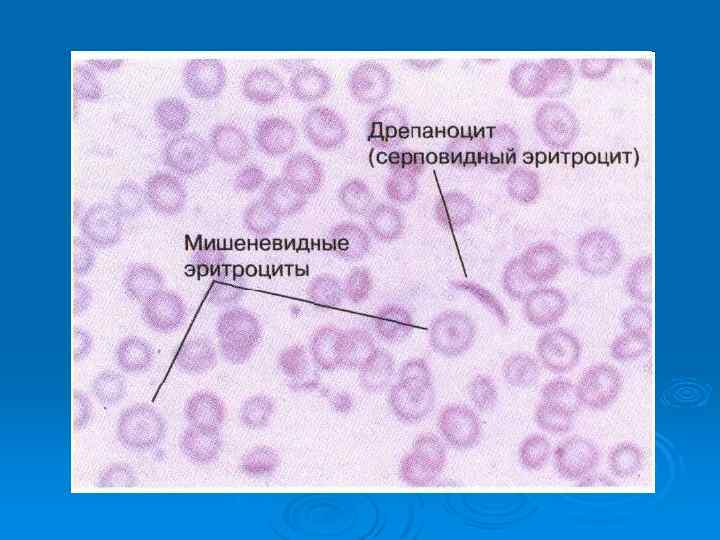

Анемия.ppt
- Количество слайдов: 150

 Основные показатели крови (гемограмма) • Эритроциты – М – 3, 9 -5, 5 х10 12 Ж – 3, 7 -4, 9 х1012 • Ретикулоциты – 5 – 12 o/oo • Гемоглобин – 120 – 150 г/л • Гематокрит – 35 – 50 % • Цветовой показатель – 0, 90 -1, 10 • Лейкоциты – 3, 8 – 9, 0 х10 9 • СОЭ – 5 – 12 мм/час • Тромбоциты – 200 – 400 х109 • Железо плазменное – 12 – 30 мкмоль/л • Общий билирубин – 8, 5 – 21 мкмоль/л
Основные показатели крови (гемограмма) • Эритроциты – М – 3, 9 -5, 5 х10 12 Ж – 3, 7 -4, 9 х1012 • Ретикулоциты – 5 – 12 o/oo • Гемоглобин – 120 – 150 г/л • Гематокрит – 35 – 50 % • Цветовой показатель – 0, 90 -1, 10 • Лейкоциты – 3, 8 – 9, 0 х10 9 • СОЭ – 5 – 12 мм/час • Тромбоциты – 200 – 400 х109 • Железо плазменное – 12 – 30 мкмоль/л • Общий билирубин – 8, 5 – 21 мкмоль/л

 Проявления острой кровопотери Объем кровопотери Признаки Данные физикального исследования Процент мл ОЦКа <20 < 1000 Беспокойство Возможна вазовагальная реакция 20 -30 10001500 Тревожность, одышка при нагрузке Ортостатическая гипотония, тахикардия при нагрузке 30 -40 15002000 Обморок при переходе в положение стоя или сидя Ортостатическая гипотония, тахикардия в покое >40 >2000 Спутанность сознания, одышка Шок, ишемия тканей а Из расчета, что ОЦК составляет 5000 мл (у взрослого весом 70 кг).
Проявления острой кровопотери Объем кровопотери Признаки Данные физикального исследования Процент мл ОЦКа <20 < 1000 Беспокойство Возможна вазовагальная реакция 20 -30 10001500 Тревожность, одышка при нагрузке Ортостатическая гипотония, тахикардия при нагрузке 30 -40 15002000 Обморок при переходе в положение стоя или сидя Ортостатическая гипотония, тахикардия в покое >40 >2000 Спутанность сознания, одышка Шок, ишемия тканей а Из расчета, что ОЦК составляет 5000 мл (у взрослого весом 70 кг).
 Компенсация острой кровопотери происходит за счет: • снижения сродства гемоглобина к кислороду - самая быстрая компенсаторная реакция при острой кровопотере - увеличение отдачи кислорода тканям благодаря сдвигу кривой диссоциации оксигемоглобина вправо вследствие ацидоза в ишемизированных тканях. • компенсаторных реакций сердечно-сосудистой системы это достигается за счет: - стимуляции работы сердца - изменение тонуса артериол при активации симпато- адреналовой системы (централизация кровотока) - выброс депонированной крови • гидремическая компенсация - активируется секреция АДГ - повышение уровня альдостерона - белковая компенсация активация протеосинтеза в печени приводит к восстановлению онкатического давления • усиления эритропоэза. - Реакция костного мозга на кровопотерю проявляется по мере увеличения секреции эритропоэтина в ответ на снижение доставки кислорода к почкам. При ускорении эритропоэза доля ретикулоцитов возрастает, при резко ускоренном эритропоэзе в крови могут появляться даже нормобласты (предшественники ретикулоцитов).
Компенсация острой кровопотери происходит за счет: • снижения сродства гемоглобина к кислороду - самая быстрая компенсаторная реакция при острой кровопотере - увеличение отдачи кислорода тканям благодаря сдвигу кривой диссоциации оксигемоглобина вправо вследствие ацидоза в ишемизированных тканях. • компенсаторных реакций сердечно-сосудистой системы это достигается за счет: - стимуляции работы сердца - изменение тонуса артериол при активации симпато- адреналовой системы (централизация кровотока) - выброс депонированной крови • гидремическая компенсация - активируется секреция АДГ - повышение уровня альдостерона - белковая компенсация активация протеосинтеза в печени приводит к восстановлению онкатического давления • усиления эритропоэза. - Реакция костного мозга на кровопотерю проявляется по мере увеличения секреции эритропоэтина в ответ на снижение доставки кислорода к почкам. При ускорении эритропоэза доля ретикулоцитов возрастает, при резко ускоренном эритропоэзе в крови могут появляться даже нормобласты (предшественники ретикулоцитов).

 Анемия - состояние, характеризующееся снижением концентрации гемоглобина и/или снижением количества эритроцитов.
Анемия - состояние, характеризующееся снижением концентрации гемоглобина и/или снижением количества эритроцитов.
 ЭРИТРОПОЭЗ
ЭРИТРОПОЭЗ
 Эритропоэтин основной регулятор эритропоэза стимулирует образование эритроцитов из поздних клеток предшественников и повышает выход ретикулоцитов из костного мозга. Синтез глобиновой м. РНК начинается со стадии проэритробласта/базофильного эритробласта. На стадии полихроматического эритробласта начинается накопление гемоглобина
Эритропоэтин основной регулятор эритропоэза стимулирует образование эритроцитов из поздних клеток предшественников и повышает выход ретикулоцитов из костного мозга. Синтез глобиновой м. РНК начинается со стадии проэритробласта/базофильного эритробласта. На стадии полихроматического эритробласта начинается накопление гемоглобина
 Основными морфологическими и биохимическими признаками эритроидной дифференцировки являются: 1) элиминация ядра с ядрышком и митохондрий; 2) синтез белков, вовлеченных в выполнение основных функций эритроидной системы (белки системы поглощения железа, глюкозамина, гемоглобин и др. ), а также 3) появление специфических мембранных антигенов
Основными морфологическими и биохимическими признаками эритроидной дифференцировки являются: 1) элиминация ядра с ядрышком и митохондрий; 2) синтез белков, вовлеченных в выполнение основных функций эритроидной системы (белки системы поглощения железа, глюкозамина, гемоглобин и др. ), а также 3) появление специфических мембранных антигенов
 Эритроцитарные индексы (MCV, MCH, MCHC): MCV — средний объём эритроцита в кубических микрометрах (мкм) или фемтолитрах (фл)(норма 80— 95 фл). В старых анализах указывали: микроцитоз, нормоцитоз, макроцитоз. Ø MCH — среднее содержание гемоглобина в отдельном эритроците в абсолютных единицах (норма 27— 31 пг). MCH — более объективный показатель, чем цветовой показатель, который не отражает синтез гемоглобина и его содержание в эритроците, а во многом зависит от объема клетки. Ø MCHC — средняя концентрация гемоглобина в эритроците (норма 330— 370 г/л), отражает степень насыщения эритроцита гемоглобином. Снижение MCHC наблюдается при заболеваниях с нарушением синтеза гемоглобина. Тем не менее, это наиболее стабильный гематологический показатель. Любая неточность, связанная с определением гемоглобина, гематокрита, MCV, приводит к увеличению MCHC, поэтому этот параметр используется как индикатор ошибки прибора или ошибки, допущенной при подготовке пробы к исследованию. Ø
Эритроцитарные индексы (MCV, MCH, MCHC): MCV — средний объём эритроцита в кубических микрометрах (мкм) или фемтолитрах (фл)(норма 80— 95 фл). В старых анализах указывали: микроцитоз, нормоцитоз, макроцитоз. Ø MCH — среднее содержание гемоглобина в отдельном эритроците в абсолютных единицах (норма 27— 31 пг). MCH — более объективный показатель, чем цветовой показатель, который не отражает синтез гемоглобина и его содержание в эритроците, а во многом зависит от объема клетки. Ø MCHC — средняя концентрация гемоглобина в эритроците (норма 330— 370 г/л), отражает степень насыщения эритроцита гемоглобином. Снижение MCHC наблюдается при заболеваниях с нарушением синтеза гемоглобина. Тем не менее, это наиболее стабильный гематологический показатель. Любая неточность, связанная с определением гемоглобина, гематокрита, MCV, приводит к увеличению MCHC, поэтому этот параметр используется как индикатор ошибки прибора или ошибки, допущенной при подготовке пробы к исследованию. Ø
 Кривые Прайс-Джонса
Кривые Прайс-Джонса






 ОБЩИЕ СИМПТОМЫ АНЕМИЙ Слабость, повышенная утомляемость, снижение работоспособности, раздражительность, сонливость Ø Головокружение, головные боли, шум в ушах, мелькание "мушек" перед глазами, Ø Сердцебиение при небольшой физической нагрузке или в покое Ø Одышка при небольшой физической нагрузке или в покое Ø
ОБЩИЕ СИМПТОМЫ АНЕМИЙ Слабость, повышенная утомляемость, снижение работоспособности, раздражительность, сонливость Ø Головокружение, головные боли, шум в ушах, мелькание "мушек" перед глазами, Ø Сердцебиение при небольшой физической нагрузке или в покое Ø Одышка при небольшой физической нагрузке или в покое Ø
 Основные критерии классификации анемий • Механизм развития – дизэритропоэтические анемии (сниженным образованием клеток эритроидного ростка , нарушенным созреванием клеток эритроидного ростка); постгеморрагические; гемолитические анемии (потерей эритроцитов вследствие их ускоренного разрушения) • Степень регенерации ретикулоцитов – гиперрегенраторные, регенераторные, гипорегенераторные, арегенераторные • Причина – первичные (наследственные и врожденные); вторичные (приобретенные) анемии • Морфология эритроцита – микроцитарные (6, 9 5, 7 мкм); нормоцитарные (7 8 мкм); макроцитарные(8, 1 9, 35 мкм); мегалоцитарные (10 15 мкм) анемии • Степень насыщения эритроцитов гемоглобином – нормохромые, гипохромные (ЦП ниже 0, 8), гиперхромные (выше 1, 0). Ц. п. – цветной показатель (0, 9 – 1, 0), находят по формуле: ц. п. = 3 Нв (г/л) / три первых цифры эритроцитов
Основные критерии классификации анемий • Механизм развития – дизэритропоэтические анемии (сниженным образованием клеток эритроидного ростка , нарушенным созреванием клеток эритроидного ростка); постгеморрагические; гемолитические анемии (потерей эритроцитов вследствие их ускоренного разрушения) • Степень регенерации ретикулоцитов – гиперрегенраторные, регенераторные, гипорегенераторные, арегенераторные • Причина – первичные (наследственные и врожденные); вторичные (приобретенные) анемии • Морфология эритроцита – микроцитарные (6, 9 5, 7 мкм); нормоцитарные (7 8 мкм); макроцитарные(8, 1 9, 35 мкм); мегалоцитарные (10 15 мкм) анемии • Степень насыщения эритроцитов гемоглобином – нормохромые, гипохромные (ЦП ниже 0, 8), гиперхромные (выше 1, 0). Ц. п. – цветной показатель (0, 9 – 1, 0), находят по формуле: ц. п. = 3 Нв (г/л) / три первых цифры эритроцитов
 КЛАССИФИКАЦИЯ АНЕМИЙ Анемии, обусловленные острой кровопотерей Анемии вследствие нарушения продукции эритроцитов Ø Ø l l l Апластические Железодефицитные Мегалобластные Сидеробластные Хронических заболеваний Анемии вследствие повышенного разрушения эритроцитов Ø l Гемолитические
КЛАССИФИКАЦИЯ АНЕМИЙ Анемии, обусловленные острой кровопотерей Анемии вследствие нарушения продукции эритроцитов Ø Ø l l l Апластические Железодефицитные Мегалобластные Сидеробластные Хронических заболеваний Анемии вследствие повышенного разрушения эритроцитов Ø l Гемолитические

 Апластическая анемия Для диагностики апластической анемии необходимо проведение дополнительных исследований: Ø Аспирационная биопсия костного мозга (цитологическое исследование) Ø Трепанобиопсия костного мозга (гистологическое исследование) Ø Цитогенетическое исследование клеток костного мозга и периферической крови Основные патогенетические механизмы : Ø аутоиммунный процесс Ø приобретенный дефект стволовых клеток
Апластическая анемия Для диагностики апластической анемии необходимо проведение дополнительных исследований: Ø Аспирационная биопсия костного мозга (цитологическое исследование) Ø Трепанобиопсия костного мозга (гистологическое исследование) Ø Цитогенетическое исследование клеток костного мозга и периферической крови Основные патогенетические механизмы : Ø аутоиммунный процесс Ø приобретенный дефект стволовых клеток



 Основными методами лечения апластической анемии являются: Аллогенная трансплантация костного мозга - при наличии родственного донора. Ø Комбинированная иммуносупрессивная терапия (антилимфоцитарный или антитимоцитарный глобулин, сандиммун) Ø Заместительная терапия компонентами крови (эритроциты, тромбоциты), Ø Профилактика и лечение инфекционных осложнений (антибактериальная, противогрибковая и противовирусная терапия) Ø
Основными методами лечения апластической анемии являются: Аллогенная трансплантация костного мозга - при наличии родственного донора. Ø Комбинированная иммуносупрессивная терапия (антилимфоцитарный или антитимоцитарный глобулин, сандиммун) Ø Заместительная терапия компонентами крови (эритроциты, тромбоциты), Ø Профилактика и лечение инфекционных осложнений (антибактериальная, противогрибковая и противовирусная терапия) Ø
 ДИСЭРИТРОПОЭТИЧЕСКИЕ АНЕМИИ группа анемий, основным признаком которых является нарушение процессов кроветворения. Как правило эти анемии вызваны дефицитом веществ необходимых для нормального эритропоэза.
ДИСЭРИТРОПОЭТИЧЕСКИЕ АНЕМИИ группа анемий, основным признаком которых является нарушение процессов кроветворения. Как правило эти анемии вызваны дефицитом веществ необходимых для нормального эритропоэза.
 В 12 -ФОЛИЕВО-ДЕФИЦИТНЫЕ АНЕМИИ Причина: дефицит витамина В 12 и фолиевой кислоты Ø Механизмы развития: Снижение синтеза пуриновых и пиримидиновых оснований, превращение рибозы в дезокси рибозу, замедление деления и созревания клеток, увеличение размеров клеток за счет избыточного гемоглобинизирования Усиление процессов внутрикостномозгового разрушения клеток до 50% при норме 20% Укорочение время жизни циркулирующих макроцитов в 3 4 раза Ø Основные принципы профилактики и лечения Диетическое питание. Заместительная терапия препаратами витамина В 12 (цианкобаламин и др. ) Ø
В 12 -ФОЛИЕВО-ДЕФИЦИТНЫЕ АНЕМИИ Причина: дефицит витамина В 12 и фолиевой кислоты Ø Механизмы развития: Снижение синтеза пуриновых и пиримидиновых оснований, превращение рибозы в дезокси рибозу, замедление деления и созревания клеток, увеличение размеров клеток за счет избыточного гемоглобинизирования Усиление процессов внутрикостномозгового разрушения клеток до 50% при норме 20% Укорочение время жизни циркулирующих макроцитов в 3 4 раза Ø Основные принципы профилактики и лечения Диетическое питание. Заместительная терапия препаратами витамина В 12 (цианкобаламин и др. ) Ø
 Причины мегалобластных анемий Дефицит витамина В 12 I. Недостаточное поступление с пищей: вегетарианцы (редко) II. Нарушения всасывания A. Недостаточность внутреннего фактора Касла 1. Болезнь Аддисона—Бирмера 2. Гастрэктомия 3. Врожденное отсутствие внутреннего фактора Касла или секреция биологически неактивного внутреннего фактора Касла (редко) Б. Поражения дистального отдела подвздошной кишки 1. Целиакия 2. Болезнь Крона 3. Резекция кишечника 4. Новообразования и гранулематозы (редко) B. Конкурентное поглощение витамина В 12 1. Дифиллоботриоз 2. Синдром слепой петли Г. Лекарственные средства: аминосалициловая кислота, колхицин, неомицин III. Другие причины А. Закись азота Б. Недостаточность транскобаламина II (редко)
Причины мегалобластных анемий Дефицит витамина В 12 I. Недостаточное поступление с пищей: вегетарианцы (редко) II. Нарушения всасывания A. Недостаточность внутреннего фактора Касла 1. Болезнь Аддисона—Бирмера 2. Гастрэктомия 3. Врожденное отсутствие внутреннего фактора Касла или секреция биологически неактивного внутреннего фактора Касла (редко) Б. Поражения дистального отдела подвздошной кишки 1. Целиакия 2. Болезнь Крона 3. Резекция кишечника 4. Новообразования и гранулематозы (редко) B. Конкурентное поглощение витамина В 12 1. Дифиллоботриоз 2. Синдром слепой петли Г. Лекарственные средства: аминосалициловая кислота, колхицин, неомицин III. Другие причины А. Закись азота Б. Недостаточность транскобаламина II (редко)
 Дефицит фолиевой кислоты I. Недостаточное поступление с пищей: неполноценное питание (больные алкоголизмом, подростки, грудные дети) II. Повышенная потребность A. Беременность Б. Грудной возраст B. Злокачественные новообразования Г. Усиление эритропоэза (хроническая гемолитическая анемия) Д. Эксфолиативнам эритродермия Е. Гемодиализ III. Нарушения всасывания 1. Целиакия 2. Лекарственные средства: фенитоин, барбитураты, этанол IV. Нарушения метаболизма фолиевой кислоты A. Ингибиторы дигидрофолатредуктазы: метотрексат, пириметамин, триамтерен, пентамидин, триметоприм Б. Алкоголь B. Недостаточность дигидрофолатредуктазы и других ферментов (редко) Другие причины I. Лекарственные средства, нарушающие синтез ДНК A. Антиметаболиты, структурные аналоги пуринов: меркаптопурин, азатиоприн, другие Б. Антиметаболиты, структурные аналоги пиримидинов: фторурацил, цитарабин, другие B. Иные лекарственные средства: прокарбазин, гидроксимочевина, ацикловир, зидовудин II. Наследственные болезни обмена веществ (редко) А. Оротовая ацидурия Б. Другие III. Мегалобластная анемия неизвестной этиологии A. Рефрактерная мегалобластная анемия Б. Острый эритромиелоз B. Наследственныедизэритропоэтические анемии
Дефицит фолиевой кислоты I. Недостаточное поступление с пищей: неполноценное питание (больные алкоголизмом, подростки, грудные дети) II. Повышенная потребность A. Беременность Б. Грудной возраст B. Злокачественные новообразования Г. Усиление эритропоэза (хроническая гемолитическая анемия) Д. Эксфолиативнам эритродермия Е. Гемодиализ III. Нарушения всасывания 1. Целиакия 2. Лекарственные средства: фенитоин, барбитураты, этанол IV. Нарушения метаболизма фолиевой кислоты A. Ингибиторы дигидрофолатредуктазы: метотрексат, пириметамин, триамтерен, пентамидин, триметоприм Б. Алкоголь B. Недостаточность дигидрофолатредуктазы и других ферментов (редко) Другие причины I. Лекарственные средства, нарушающие синтез ДНК A. Антиметаболиты, структурные аналоги пуринов: меркаптопурин, азатиоприн, другие Б. Антиметаболиты, структурные аналоги пиримидинов: фторурацил, цитарабин, другие B. Иные лекарственные средства: прокарбазин, гидроксимочевина, ацикловир, зидовудин II. Наследственные болезни обмена веществ (редко) А. Оротовая ацидурия Б. Другие III. Мегалобластная анемия неизвестной этиологии A. Рефрактерная мегалобластная анемия Б. Острый эритромиелоз B. Наследственныедизэритропоэтические анемии


 ЖЕЛЕЗОДЕФИЦИТНАЯ АНЕМИЯ • Причина: Потери железа более 2 мг в сутки • Патогенез: Дефицит железа – торможение образования гемоглобина – анемия • Основные принципы профилактики и лечения: Ликвидация причины, вызвавшей дефицит железа. Диета с высоким содержанием железа (мясо, печень и др. ). Длительный прием препаратов железа (4 6 мес. ). Парентеральные препараты железа (по показаниям). Переливания эритроцитарной массы при тяжелой анемии. Профилактический прием препаратов железа в группах риска.
ЖЕЛЕЗОДЕФИЦИТНАЯ АНЕМИЯ • Причина: Потери железа более 2 мг в сутки • Патогенез: Дефицит железа – торможение образования гемоглобина – анемия • Основные принципы профилактики и лечения: Ликвидация причины, вызвавшей дефицит железа. Диета с высоким содержанием железа (мясо, печень и др. ). Длительный прием препаратов железа (4 6 мес. ). Парентеральные препараты железа (по показаниям). Переливания эритроцитарной массы при тяжелой анемии. Профилактический прием препаратов железа в группах риска.
 Причины потери железа Кровопотеря. Желудочно-кишечное кровотечение. Внутрисосудистый гемолиз. Кровопотеря при хирургическом вмешательстве. Тяжелые нарушения всасывания. Гастрэктомия и резекция желудка. Хронические воспалительные заболевания кишечника.
Причины потери железа Кровопотеря. Желудочно-кишечное кровотечение. Внутрисосудистый гемолиз. Кровопотеря при хирургическом вмешательстве. Тяжелые нарушения всасывания. Гастрэктомия и резекция желудка. Хронические воспалительные заболевания кишечника.

Патология ногтей, развивающаяся при длительно существующем дефиците железа: так называемые "койлонихии" - ложкообразные ногти. В редких случаях бывают врожденной аномалией и не свидетельствуют об анемии Ярко-красный язык и заеды в углах рта при анемии
Патология ногтей, развивающаяся при длительно существующем дефиците железа: так называемые "койлонихии" - ложкообразные ногти. В редких случаях бывают врожденной аномалией и не свидетельствуют об анемии Ярко-красный язык и заеды в углах рта при анемии
 ЖЕЛЕЗОРЕФРАКТЕРНАЯ АНЕМИЯ Ø Причина: В костном мозге нарушается включение железа в молекулу гема и синтеза гемоглобина – увеличение железа в плазме и клетках различных органов. В костном мозге увеличиваются содержание сидеробластов
ЖЕЛЕЗОРЕФРАКТЕРНАЯ АНЕМИЯ Ø Причина: В костном мозге нарушается включение железа в молекулу гема и синтеза гемоглобина – увеличение железа в плазме и клетках различных органов. В костном мозге увеличиваются содержание сидеробластов

 Ретикулоциты при окраске бриллиантовым кризиловым синим. Внутри клеток хорошо видна зернисто-нитчатая субстанция
Ретикулоциты при окраске бриллиантовым кризиловым синим. Внутри клеток хорошо видна зернисто-нитчатая субстанция
 Проявления острой кровопотери Объем кровопотери Признаки Данные физикального исследования Процент мл ОЦКа <20 < 1000 Беспокойство Возможна вазовагальная реакция 20 -30 10001500 Тревожность, одышка при нагрузке Ортостатическая гипотония, тахикардия при нагрузке 30 -40 15002000 Обморок при переходе в положение стоя или сидя Ортостатическая гипотония, тахикардия в покое >40 >2000 Спутанность сознания, одышка Шок, ишемия тканей а Из расчета, что ОЦК составляет 5000 мл (у взрослого весом 70 кг).
Проявления острой кровопотери Объем кровопотери Признаки Данные физикального исследования Процент мл ОЦКа <20 < 1000 Беспокойство Возможна вазовагальная реакция 20 -30 10001500 Тревожность, одышка при нагрузке Ортостатическая гипотония, тахикардия при нагрузке 30 -40 15002000 Обморок при переходе в положение стоя или сидя Ортостатическая гипотония, тахикардия в покое >40 >2000 Спутанность сознания, одышка Шок, ишемия тканей а Из расчета, что ОЦК составляет 5000 мл (у взрослого весом 70 кг).

 Компенсация острой кровопотери происходит за счет: • снижения сродства гемоглобина к кислороду - самая быстрая компенсаторная реакция при острой кровопотере - увеличение отдачи кислорода тканям благодаря сдвигу кривой диссоциации оксигемоглобина вправо вследствие ацидоза в ишемизированных тканях. • компенсаторных реакций сердечно-сосудистой системы это достигается за счет: - стимуляции работы сердца - изменение тонуса артериол при активации симпато- адреналовой системы (централизация кровотока) - выброс депонированной крови • гидремическая компенсация - активируется секреция АДГ - повышение уровня альдостерона - белковая компенсация активация протеосинтеза в печени приводит к восстановлению онкатического давления • усиления эритропоэза. - Реакция костного мозга на кровопотерю проявляется по мере увеличения секреции эритропоэтина в ответ на снижение доставки кислорода к почкам. При ускорении эритропоэза доля ретикулоцитов возрастает, при резко ускоренном эритропоэзе в крови могут появляться даже нормобласты (предшественники ретикулоцитов).
Компенсация острой кровопотери происходит за счет: • снижения сродства гемоглобина к кислороду - самая быстрая компенсаторная реакция при острой кровопотере - увеличение отдачи кислорода тканям благодаря сдвигу кривой диссоциации оксигемоглобина вправо вследствие ацидоза в ишемизированных тканях. • компенсаторных реакций сердечно-сосудистой системы это достигается за счет: - стимуляции работы сердца - изменение тонуса артериол при активации симпато- адреналовой системы (централизация кровотока) - выброс депонированной крови • гидремическая компенсация - активируется секреция АДГ - повышение уровня альдостерона - белковая компенсация активация протеосинтеза в печени приводит к восстановлению онкатического давления • усиления эритропоэза. - Реакция костного мозга на кровопотерю проявляется по мере увеличения секреции эритропоэтина в ответ на снижение доставки кислорода к почкам. При ускорении эритропоэза доля ретикулоцитов возрастает, при резко ускоренном эритропоэзе в крови могут появляться даже нормобласты (предшественники ретикулоцитов).
 Первые часы и сутки. • Нормоцитемическая гиповолемия (эквивалентное уменьшение общего содержания форменных элементов и плазмы крови). • Снижение показателя объёма циркулирующих эритроцитов. • Ht, число эритроцитов, уровень Нb в единице объёма крови в пределах нормы. 2— 3 -й сутки после кровопотери. • Снижение уровня Нb ниже нормы. • Уменьшение числа эритроцитов в единице объёма крови и падение Ht. • Сохранение в пределах нормы цветового показателя (в связи с тем что в крови циркулируют зрелые эритроциты, находившиеся в сосудистом русле, в том числе в депо, до кровопотери). Тромбоцитопения (в результате потребления кровяных пластинок в процессе тромбообразования, гемодилюции, а также утраты их при кровопотере). Лейкопения (вследствие потери лейкоцитов во время кровотечения и после дующей гемодилюции). 4— 5 -е сутки после кровопотери. Пониженное содержание Нb, эритропения, сниженный Ht. Гипохромия эритроцитов (цветовой показатель ниже 0, 85). Увеличение числа молодых клеток эритроидного ряда (как результат высокой регенераторной способности костного мозга). Тромбоцитопения и лейкопения.
Первые часы и сутки. • Нормоцитемическая гиповолемия (эквивалентное уменьшение общего содержания форменных элементов и плазмы крови). • Снижение показателя объёма циркулирующих эритроцитов. • Ht, число эритроцитов, уровень Нb в единице объёма крови в пределах нормы. 2— 3 -й сутки после кровопотери. • Снижение уровня Нb ниже нормы. • Уменьшение числа эритроцитов в единице объёма крови и падение Ht. • Сохранение в пределах нормы цветового показателя (в связи с тем что в крови циркулируют зрелые эритроциты, находившиеся в сосудистом русле, в том числе в депо, до кровопотери). Тромбоцитопения (в результате потребления кровяных пластинок в процессе тромбообразования, гемодилюции, а также утраты их при кровопотере). Лейкопения (вследствие потери лейкоцитов во время кровотечения и после дующей гемодилюции). 4— 5 -е сутки после кровопотери. Пониженное содержание Нb, эритропения, сниженный Ht. Гипохромия эритроцитов (цветовой показатель ниже 0, 85). Увеличение числа молодых клеток эритроидного ряда (как результат высокой регенераторной способности костного мозга). Тромбоцитопения и лейкопения.
 Гемолитические анемии В обширную группу гемолитических анемий входят разнообразные заболевания, объединенные одним общим признаком – укорочением продолжительности жизни эритроцитов. Механизм развития этого вида анемии связан с повышенным разрушением (гемолизом) эритроцитов. В результате повышенного гемолиза эритроцитов в крови накапливается большое количество непрямого билирубина, что приводит к развитию желтухи.
Гемолитические анемии В обширную группу гемолитических анемий входят разнообразные заболевания, объединенные одним общим признаком – укорочением продолжительности жизни эритроцитов. Механизм развития этого вида анемии связан с повышенным разрушением (гемолизом) эритроцитов. В результате повышенного гемолиза эритроцитов в крови накапливается большое количество непрямого билирубина, что приводит к развитию желтухи.
 Причины появления патологического гемолиза Ø Наследственные нарушения строения эритроцитов – наследственные гемолитические анемии. Ø Воздействие на эритроциты каких-либо внешних факторов, которые вызывают гемолиз – приобретенные гемолитические анемии.
Причины появления патологического гемолиза Ø Наследственные нарушения строения эритроцитов – наследственные гемолитические анемии. Ø Воздействие на эритроциты каких-либо внешних факторов, которые вызывают гемолиз – приобретенные гемолитические анемии.

 Наследственные гемолитические анемии. Мембранопатии Энзимопатии Гемоглобинопатии
Наследственные гемолитические анемии. Мембранопатии Энзимопатии Гемоглобинопатии
 Мембранопатия эритроцитов микросфероцитоз стоматоцитоз овалоцитоз пиропойкилоцитоз
Мембранопатия эритроцитов микросфероцитоз стоматоцитоз овалоцитоз пиропойкилоцитоз


 Наследственный микросфероцитоз Заболевание характеризуется появлением шаровидных эритроцитов (микросфероцитов ) и обусловлено дефектом одного из белков цитоскелета эритроцитов. Генетические дефекты затрагивают белки цитоскелета эритроцитов, которые связывают цитоскелет с мембраной. В результате теряется часть мембраны эритроцита, уменьшается отношение площади поверхности к объему, и эритроцит превращается в микросфероцит. Основные проявления - анемия, спленомегалия и желтуха. В костном мозге возникает компенсаторная гиперплазия эритроидного ростка. Регенераторные возможности костного мозга в 6 -8 раз превышают обычную для этого заболевания скорость распада эритроцитов, поэтому анемия , как правило, бывает легкой или умеренной. Время от времени возникают апластические кризы , спровоцированные инфекцией.
Наследственный микросфероцитоз Заболевание характеризуется появлением шаровидных эритроцитов (микросфероцитов ) и обусловлено дефектом одного из белков цитоскелета эритроцитов. Генетические дефекты затрагивают белки цитоскелета эритроцитов, которые связывают цитоскелет с мембраной. В результате теряется часть мембраны эритроцита, уменьшается отношение площади поверхности к объему, и эритроцит превращается в микросфероцит. Основные проявления - анемия, спленомегалия и желтуха. В костном мозге возникает компенсаторная гиперплазия эритроидного ростка. Регенераторные возможности костного мозга в 6 -8 раз превышают обычную для этого заболевания скорость распада эритроцитов, поэтому анемия , как правило, бывает легкой или умеренной. Время от времени возникают апластические кризы , спровоцированные инфекцией.
 Спленомегалия наблюдается почти всегда. Иногда возникают хронические язвы ног - такие же, как при серповидноклеточной анемии. Характерное изменение эритроцитов - микросфероцитоз. В мазке крови микросфероциты имеют вид мелких клеток без центрального просветления. Количественным показателем сферичности эритроцитов служит их осмотическая стойкость. Поскольку у микросфероцитов снижено отношение площади поверхности к объему, они способны вместить меньше воды и гемолизируются в гораздо менее гипотоничных растворах, чем нормальные эритроциты. Пока содержание микросфероцитов не превышает 1 -2%, результаты этого исследования остаются в пределах нормы. Другой характерный признак наследственного микросфероцитоза - еще большее снижение осмотической стойкости эритроцитов после инкубации крови в течение 24 ч при 37 градусах по С.
Спленомегалия наблюдается почти всегда. Иногда возникают хронические язвы ног - такие же, как при серповидноклеточной анемии. Характерное изменение эритроцитов - микросфероцитоз. В мазке крови микросфероциты имеют вид мелких клеток без центрального просветления. Количественным показателем сферичности эритроцитов служит их осмотическая стойкость. Поскольку у микросфероцитов снижено отношение площади поверхности к объему, они способны вместить меньше воды и гемолизируются в гораздо менее гипотоничных растворах, чем нормальные эритроциты. Пока содержание микросфероцитов не превышает 1 -2%, результаты этого исследования остаются в пределах нормы. Другой характерный признак наследственного микросфероцитоза - еще большее снижение осмотической стойкости эритроцитов после инкубации крови в течение 24 ч при 37 градусах по С.
 Наследственный овалоцитоз Овальными эритроциты становятся потому, что не восстанавливают свою первоначальную форму двояковогнутого диска после прохождения по микроциркуляторному руслу. У больных обнаружена недостаточность спектрина, белка полосы 4. 1 , связывающего спектрин и актин. В Юго-Восточной Азии широко распространен наследственный овалоцитоз, обусловленный делецией гена белка полосы 3. Этот дефект делает мембрану эритроцита ригидной и защищает эритроциты от внедрения малярийных плазмодиев.
Наследственный овалоцитоз Овальными эритроциты становятся потому, что не восстанавливают свою первоначальную форму двояковогнутого диска после прохождения по микроциркуляторному руслу. У больных обнаружена недостаточность спектрина, белка полосы 4. 1 , связывающего спектрин и актин. В Юго-Восточной Азии широко распространен наследственный овалоцитоз, обусловленный делецией гена белка полосы 3. Этот дефект делает мембрану эритроцита ригидной и защищает эритроциты от внедрения малярийных плазмодиев.
 У подавляющего большинства больных: - легкий гемолиз - концентрация гемоглобина превышает 120 г/л - ретикулоцитов менее 4% - концентрация гаптоглобина снижена - срок жизни эритроцитов незначительно уменьшен. При тяжелых нарушениях: - срок жизни половины эритроцитов не превышает 5 сут - содержание ретикулоцитов достигает 20% - концентрация гемоглобина редко бывает ниже 90 -100 г/л. Осмотическая стойкость эритроцитов в норме или понижена.
У подавляющего большинства больных: - легкий гемолиз - концентрация гемоглобина превышает 120 г/л - ретикулоцитов менее 4% - концентрация гаптоглобина снижена - срок жизни эритроцитов незначительно уменьшен. При тяжелых нарушениях: - срок жизни половины эритроцитов не превышает 5 сут - содержание ретикулоцитов достигает 20% - концентрация гемоглобина редко бывает ниже 90 -100 г/л. Осмотическая стойкость эритроцитов в норме или понижена.
 Наследственный пиропойкилоцитоз имеет ту же природу, что и наследственный овалоцитоз. Причина - недостаточность спектрина и нарушение его самосборки. Для него характерны пойкилоцитоз , микроцитоз и разрушение эритроцитов при нагревании до 44 -45 градусов по С (нормальные эритроциты выдерживают температуру до 49 градусов по С). Гемолиз обычно тяжелый, проявляется с детства.
Наследственный пиропойкилоцитоз имеет ту же природу, что и наследственный овалоцитоз. Причина - недостаточность спектрина и нарушение его самосборки. Для него характерны пойкилоцитоз , микроцитоз и разрушение эритроцитов при нагревании до 44 -45 градусов по С (нормальные эритроциты выдерживают температуру до 49 градусов по С). Гемолиз обычно тяжелый, проявляется с детства.
 Наследственный стоматоцитоз Стоматоцитами называются эритроциты , вогнутые с одной стороны и выпуклые с другой. Повышена проницаемость мембраны эритроцитов для калия и натрия. У одних больных эритроциты набухшие, с высоким содержанием ионов и воды и низкой средней концентрацией гемоглобина (гипергидратированные стоматоциты, гидроцитоз ). У других больных эритроциты сморщенные, с низким содержанием ионов и воды и высокой средней концентрацией гемоглобина (дегидратированные стоматоциты, ксероцитоз ). Осмотическая стойкость снижена у гипергидратированных стоматоцитов и повышена у дегидратированных. У большинства больных обнаруживают спленомегалию и легкую анемию.
Наследственный стоматоцитоз Стоматоцитами называются эритроциты , вогнутые с одной стороны и выпуклые с другой. Повышена проницаемость мембраны эритроцитов для калия и натрия. У одних больных эритроциты набухшие, с высоким содержанием ионов и воды и низкой средней концентрацией гемоглобина (гипергидратированные стоматоциты, гидроцитоз ). У других больных эритроциты сморщенные, с низким содержанием ионов и воды и высокой средней концентрацией гемоглобина (дегидратированные стоматоциты, ксероцитоз ). Осмотическая стойкость снижена у гипергидратированных стоматоцитов и повышена у дегидратированных. У большинства больных обнаруживают спленомегалию и легкую анемию.
 Ферментопатии эритроцитов АТФ образуется в процессе анаэробного гликолиза и уходит главным образом на обеспечение работы Na+, K+-АТФазы, поддерживающей ионный состав эритроцита. Небольшое количество энергии идет на сохранение железа гема в восстановленной форме и, по-видимому, на обновление липидов мембраны. Примерно 10% глюкозы, метаболизируетс я по пентозофосфатн ому пути. Он обеспечивает защиту гемоглобина и мембраны эритроцита от экзогенных окислителей
Ферментопатии эритроцитов АТФ образуется в процессе анаэробного гликолиза и уходит главным образом на обеспечение работы Na+, K+-АТФазы, поддерживающей ионный состав эритроцита. Небольшое количество энергии идет на сохранение железа гема в восстановленной форме и, по-видимому, на обновление липидов мембраны. Примерно 10% глюкозы, метаболизируетс я по пентозофосфатн ому пути. Он обеспечивает защиту гемоглобина и мембраны эритроцита от экзогенных окислителей
 Морфологические изменения эритроцитов свидетельствуют о том, что при ферментопатиях вторично страдает их мембрана. Среди всех случаев недостаточности ферментов гликолиза примерно 95% приходится на недостаточность пируваткиназы. Самая распространенная ферментопатия пентозофосфатного пути - это недостаточность Г-6 -ФД.
Морфологические изменения эритроцитов свидетельствуют о том, что при ферментопатиях вторично страдает их мембрана. Среди всех случаев недостаточности ферментов гликолиза примерно 95% приходится на недостаточность пируваткиназы. Самая распространенная ферментопатия пентозофосфатного пути - это недостаточность Г-6 -ФД.

 Лекарственные средства, вызывающие гемолиз у больных с недостаточностью Г-6 -ФД: - Противомалярийные средства: примахин, памахин - Препараты, содержащие сульфоновую группу: дапсон - Сульфаниламиды (в частности сульфаметаксозол) - Нитрофурантоин - Анальгетики: ацетанилид, феназопиридин - Другие: менадион, доксорубицин, метиленовый синий, налидиксовая кислота, фуразолидон, ниридазолугие
Лекарственные средства, вызывающие гемолиз у больных с недостаточностью Г-6 -ФД: - Противомалярийные средства: примахин, памахин - Препараты, содержащие сульфоновую группу: дапсон - Сульфаниламиды (в частности сульфаметаксозол) - Нитрофурантоин - Анальгетики: ацетанилид, феназопиридин - Другие: менадион, доксорубицин, метиленовый синий, налидиксовая кислота, фуразолидон, ниридазолугие
 Гемоглобинопатия - группа наследственных заболеваний, обусловленных присутствием в эритроцитах дефектных глобинов.
Гемоглобинопатия - группа наследственных заболеваний, обусловленных присутствием в эритроцитах дефектных глобинов.
 I. Наследственные А Качественные гемоглобинопатии 1. Гемоглобинопатии S 2. Гемоглобинопатии С 3. Гемоглобинопатии L 4. Нестабильные гемоглобины 5. Гемоглобины с измененным сродством к кислороду 6. Наследственная метгемоглобинемия (гемоглобинопатии М) Б. Количественные гемоглобинопатии (талассемии) 1. Альфа-талассемии 2. Бета-талассемии (в том числе наследственная персистенция гемоглобина F) В. Смешанные гемоглобинопатии 1. Нb. Е-b-талассемия 2. Hb. S-b-талассемия 3. Нb. С-b-талассемия Г. Наследственная метгемоглобинемия (недостаточность НАДНметгемоглобинредуктазы) II. Приобретенные 1. Сульфгемоглобинемия 2. Метгемоглобинемия 3. Карбоксигемоглобинемия
I. Наследственные А Качественные гемоглобинопатии 1. Гемоглобинопатии S 2. Гемоглобинопатии С 3. Гемоглобинопатии L 4. Нестабильные гемоглобины 5. Гемоглобины с измененным сродством к кислороду 6. Наследственная метгемоглобинемия (гемоглобинопатии М) Б. Количественные гемоглобинопатии (талассемии) 1. Альфа-талассемии 2. Бета-талассемии (в том числе наследственная персистенция гемоглобина F) В. Смешанные гемоглобинопатии 1. Нb. Е-b-талассемия 2. Hb. S-b-талассемия 3. Нb. С-b-талассемия Г. Наследственная метгемоглобинемия (недостаточность НАДНметгемоглобинредуктазы) II. Приобретенные 1. Сульфгемоглобинемия 2. Метгемоглобинемия 3. Карбоксигемоглобинемия
 А. Трансмиссионная электронная микроскопия Б. Растровая электронная микроскопия
А. Трансмиссионная электронная микроскопия Б. Растровая электронная микроскопия
Механизмы повреждения эритроцитов при -талассемии дефицит -цепей избыточная продукция -цепей преципитация -цепей и потеря ими гемов накопление железа (в виде гранул гемосидерина) увеличение пула свободного железа пероксидазное повреждение мембран эритроцитов повышение проницаемости мембран для ионов кальция активация трансглютаминазы синтез глютамил-лизиновых мостиков ригидность мембраны эритроцитов
Механизмы повреждения эритроцитов при -талассемии дефицит -цепей избыточная продукция -цепей преципитация -цепей и потеря ими гемов накопление железа (в виде гранул гемосидерина) увеличение пула свободного железа пероксидазное повреждение мембран эритроцитов повышение проницаемости мембран для ионов кальция активация трансглютаминазы синтез глютамил-лизиновых мостиков ригидность мембраны эритроцитов
 Картина крови при талассемии Для талассемии характерно появ-ление в крови так называемых «мишеневидных» эритроцитов.
Картина крови при талассемии Для талассемии характерно появ-ление в крови так называемых «мишеневидных» эритроцитов.

 Классификация приобретенных гемолитических анемий I. Гемолитическая анемия при гиперспленизме II. Иммунные гемолитические анемии A. Аутоиммунная гемолитическая анемия с тепловыми антителами Б. Аутоиммунная гемолитическая анемия с Холодовыми антителами B. Пароксизмальная холодовая гемоглобинурия Г. Лекарственная иммунная гемолитическая анемия 1. Аутоиммунная 2. Гаптенная III. Гемолитические анемии, обусловленные механическим повреждением эритроцитов A. Маршевая гемоглобинурия Б. Гемолитическая анемия при протезировании клапанов сердца и сосудов B. Микроангиопатическая гемолитическая анемия 1. Тромботическая громбопитопеническая пурпура и гемолитико-уремический синдром 2. Патология сосудистой стенки 3. ДВС-синдром IV. Токсические гемолитические анемии А. Шпороклеточная анемия Б. Внешние токсические воздействия 1. Укусы змей и пауков 2. Металлы (например, медь) 3. Органические вещества V. Пароксизмальная ночная гемоглобинурия
Классификация приобретенных гемолитических анемий I. Гемолитическая анемия при гиперспленизме II. Иммунные гемолитические анемии A. Аутоиммунная гемолитическая анемия с тепловыми антителами Б. Аутоиммунная гемолитическая анемия с Холодовыми антителами B. Пароксизмальная холодовая гемоглобинурия Г. Лекарственная иммунная гемолитическая анемия 1. Аутоиммунная 2. Гаптенная III. Гемолитические анемии, обусловленные механическим повреждением эритроцитов A. Маршевая гемоглобинурия Б. Гемолитическая анемия при протезировании клапанов сердца и сосудов B. Микроангиопатическая гемолитическая анемия 1. Тромботическая громбопитопеническая пурпура и гемолитико-уремический синдром 2. Патология сосудистой стенки 3. ДВС-синдром IV. Токсические гемолитические анемии А. Шпороклеточная анемия Б. Внешние токсические воздействия 1. Укусы змей и пауков 2. Металлы (например, медь) 3. Органические вещества V. Пароксизмальная ночная гемоглобинурия
 В норме селезенка задерживает ретикулоциты на 1 -2 сут, но не создает препятствий нормальным эритроцитам, за исключением стареющих Спленомегалия сопровождается усиленным разрушением клеток крови, в том числе эритроцитов, чему способствует задержка крови в среде, бедной питательными веществами и богатой фагоцитами
В норме селезенка задерживает ретикулоциты на 1 -2 сут, но не создает препятствий нормальным эритроцитам, за исключением стареющих Спленомегалия сопровождается усиленным разрушением клеток крови, в том числе эритроцитов, чему способствует задержка крови в среде, бедной питательными веществами и богатой фагоцитами
 Аутоантитела к антигенам эритроцитов либо непосредственно лизируют клетки в присутствии комплемента , либо комплекс эритроцит: антитело захватывается и разрушается фагоцитами. Основной метод диагностики аутоиммунных гемолитических анемий - проба Кумбса. В основе ее лежит способность антител, специфичных к иммуноглобулинам (особенно к Ig. G ) или компонентам комплемента (особенно СЗ ), агглютинировать эритроциты, покрытые Ig. G или СЗ
Аутоантитела к антигенам эритроцитов либо непосредственно лизируют клетки в присутствии комплемента , либо комплекс эритроцит: антитело захватывается и разрушается фагоцитами. Основной метод диагностики аутоиммунных гемолитических анемий - проба Кумбса. В основе ее лежит способность антител, специфичных к иммуноглобулинам (особенно к Ig. G ) или компонентам комплемента (особенно СЗ ), агглютинировать эритроциты, покрытые Ig. G или СЗ
 Гемолиз вследствие механического повреждения наблюдается в трех случаях - когда они преодолевают градиент давления, проходя через протезированные и деформированные клапаны сердца, и на их мембрану действует значительная сила сдвига (гемолитическая анемия при протезировании сосудов и клапанов сердца ; - когда эритроциты, проходя по мелким сосудам над костным выступами, подвергаются сдавлению извне ( маршевая гемоглобинурия ); - когда они проходят по мелким сосудам, на стенках которых отложен фибрин (микроангиопатическая гемолитическая анемия ).
Гемолиз вследствие механического повреждения наблюдается в трех случаях - когда они преодолевают градиент давления, проходя через протезированные и деформированные клапаны сердца, и на их мембрану действует значительная сила сдвига (гемолитическая анемия при протезировании сосудов и клапанов сердца ; - когда эритроциты, проходя по мелким сосудам над костным выступами, подвергаются сдавлению извне ( маршевая гемоглобинурия ); - когда они проходят по мелким сосудам, на стенках которых отложен фибрин (микроангиопатическая гемолитическая анемия ).
 К гемолизу может привести повреждение мембраны эритроцитов различными внешними факторами, в том числе химическими и бактериальными. Шпороклеточная анемия развивается у больных с тяжелыми паренхиматозными заболеваниями печени.
К гемолизу может привести повреждение мембраны эритроцитов различными внешними факторами, в том числе химическими и бактериальными. Шпороклеточная анемия развивается у больных с тяжелыми паренхиматозными заболеваниями печени.

 Основные факторы дифференцировки • Интерлейкин-3 (ИЛ-3) – ростовой и дифференцирующий фактор для наиболее ранних предшественников кроветворных клеток ИЛ-3 стимулирует пролиферацию и дифференцировку промежуточных клетокпредшественников, а также дифференцировку поздних клетокпредшественников в мегакариоциты, гранулоциты, моноциты и эритроциты. • ГМ-КСФ – стимулирует дифференцировку поздних клетокпредшественников в нейтрофилы, эозинофилы и моноциты. Кроме того, он стимулирует пролиферацию промежуточных клетокпредшественников. • Г-КСФ – является основным гемопоэтическим фактором роста, который обеспечивает пролиферацию, дифференцировку и терминальное созревание миелоидных предшественников нейтрофильных гранулоцитов, а также стимулирует разнообразные функции зрелых нейтрофилов и увеличивает продолжительность их жизни. • Интерлейкин-7 (ИЛ-7) - ростовой и дифференцирующий фактор для пре -В и пре-Т лимфоцитов
Основные факторы дифференцировки • Интерлейкин-3 (ИЛ-3) – ростовой и дифференцирующий фактор для наиболее ранних предшественников кроветворных клеток ИЛ-3 стимулирует пролиферацию и дифференцировку промежуточных клетокпредшественников, а также дифференцировку поздних клетокпредшественников в мегакариоциты, гранулоциты, моноциты и эритроциты. • ГМ-КСФ – стимулирует дифференцировку поздних клетокпредшественников в нейтрофилы, эозинофилы и моноциты. Кроме того, он стимулирует пролиферацию промежуточных клетокпредшественников. • Г-КСФ – является основным гемопоэтическим фактором роста, который обеспечивает пролиферацию, дифференцировку и терминальное созревание миелоидных предшественников нейтрофильных гранулоцитов, а также стимулирует разнообразные функции зрелых нейтрофилов и увеличивает продолжительность их жизни. • Интерлейкин-7 (ИЛ-7) - ростовой и дифференцирующий фактор для пре -В и пре-Т лимфоцитов
 Лейкоцитарная формула Лейкоциты 4, 0. 109/л – 8, 8. 109/л Палочкоядерные нейтрофилы 1, 0 – 6, 0 % Сегментоядерные нейтрофилы 45, 0 – 70, 0 % Эозинофилы 0, 0 – 5, 0 % Моноциты 2, 0 – 9, 0 % Базофилы 0. 25 – 1. 0 % Лимфоциты 18, 0 – 40, 0 %
Лейкоцитарная формула Лейкоциты 4, 0. 109/л – 8, 8. 109/л Палочкоядерные нейтрофилы 1, 0 – 6, 0 % Сегментоядерные нейтрофилы 45, 0 – 70, 0 % Эозинофилы 0, 0 – 5, 0 % Моноциты 2, 0 – 9, 0 % Базофилы 0. 25 – 1. 0 % Лимфоциты 18, 0 – 40, 0 %
 ЛЕЙКОЦИТОЗ УВЕЛИЧЕНИЕ ЧИСЛА ЛЕЙКОЦИТОВ В ЕДИНИЦЕ ОБЪЕМА КРОВИ (БОЛЕЕ 9 х109/л). К физиологическим лейкоцитозам относят: Ø 1) алиментарный (пищеварительный), развивающийся через 2 3 ч после приема пищи; Ø 2) миогенный при мышечном напряжении; Ø 3) эмоциональный вследствие психического возбуждения; Ø 4) лейкоцитоз новорожденных
ЛЕЙКОЦИТОЗ УВЕЛИЧЕНИЕ ЧИСЛА ЛЕЙКОЦИТОВ В ЕДИНИЦЕ ОБЪЕМА КРОВИ (БОЛЕЕ 9 х109/л). К физиологическим лейкоцитозам относят: Ø 1) алиментарный (пищеварительный), развивающийся через 2 3 ч после приема пищи; Ø 2) миогенный при мышечном напряжении; Ø 3) эмоциональный вследствие психического возбуждения; Ø 4) лейкоцитоз новорожденных
 К патологическим лейкоцитозам относятся: Ø 1) инфекционный при пневмонии, менингите, скарлатине и ряде других инфекционных заболеваний; Ø 2) воспалительный (особенно при гнойных воспалительных процессах) при различного рода травмах: повреждении электрическим током, действий высокой и низкой температуры и т. д. ; Ø 3) токсогенный при действии вредных веществ как экзогенного (бензол, мышьяковистый водород, анилин и др. ), так и эндогенного происхождения (при уремии, диабетической коме); Ø 4) постгеморрагический наступающий после острых кровопотерь; Ø 5) "новообразовательный" при распаде опухолей; Ø 6) "лейкемический" при острых и хронических лейкозах. Ø 7) "центрогенный" при шоковых состояниях, эпилепсии, агонии; послеоперационный.
К патологическим лейкоцитозам относятся: Ø 1) инфекционный при пневмонии, менингите, скарлатине и ряде других инфекционных заболеваний; Ø 2) воспалительный (особенно при гнойных воспалительных процессах) при различного рода травмах: повреждении электрическим током, действий высокой и низкой температуры и т. д. ; Ø 3) токсогенный при действии вредных веществ как экзогенного (бензол, мышьяковистый водород, анилин и др. ), так и эндогенного происхождения (при уремии, диабетической коме); Ø 4) постгеморрагический наступающий после острых кровопотерь; Ø 5) "новообразовательный" при распаде опухолей; Ø 6) "лейкемический" при острых и хронических лейкозах. Ø 7) "центрогенный" при шоковых состояниях, эпилепсии, агонии; послеоперационный.
 Механизмы развития лейкоцитозов Ø Усиление лейкопоэза Ø Перераспределение в сосудистом русле Ø Гемоконцентрация Ø Лейкозы
Механизмы развития лейкоцитозов Ø Усиление лейкопоэза Ø Перераспределение в сосудистом русле Ø Гемоконцентрация Ø Лейкозы
 Лейкопения - уменьшение общего количества лейкоцитов ниже 4 х109/л.
Лейкопения - уменьшение общего количества лейкоцитов ниже 4 х109/л.
 Механизмы развития лейкопений Ø Нарушение или угнетение лейкопоэза Ø Усиленное разрушение лейкоцитов Ø Перераспределение лейкоцитов Ø Кровопотеря Ø Гемодилюция
Механизмы развития лейкопений Ø Нарушение или угнетение лейкопоэза Ø Усиленное разрушение лейкоцитов Ø Перераспределение лейкоцитов Ø Кровопотеря Ø Гемодилюция
 Нейтрофилы Неделящиеся клетки с многодольчатым (сегментированным) ядром. Ø Время их нахождения в кровеносном русле в среднем составляет 6 - 8 ч, так как они быстро мигрируют в слизистые оболочки. Ø Основная функция – неспецифический иммунитет. Ø Механизмы действия нейтрофилов l фагоцитоз l образование кислородных радикалов l секреция различных ферментов деградации Ø
Нейтрофилы Неделящиеся клетки с многодольчатым (сегментированным) ядром. Ø Время их нахождения в кровеносном русле в среднем составляет 6 - 8 ч, так как они быстро мигрируют в слизистые оболочки. Ø Основная функция – неспецифический иммунитет. Ø Механизмы действия нейтрофилов l фагоцитоз l образование кислородных радикалов l секреция различных ферментов деградации Ø
 нейтрофил
нейтрофил

 адгезия
адгезия


 Нейтрофильный лейкоцитоз 1) без ядерного сдвига Ø 2) с гипорегенеративным ядерным сдвигом влево Ø 3) с регенеративным ядерным сдвигом влево Ø 4) с гиперрегенеративным ядерным сдвигом влево Ø 5) с дегенеративным ядерным сдвигом Ø 6) с ядерным сдвигом вправо Ø
Нейтрофильный лейкоцитоз 1) без ядерного сдвига Ø 2) с гипорегенеративным ядерным сдвигом влево Ø 3) с регенеративным ядерным сдвигом влево Ø 4) с гиперрегенеративным ядерным сдвигом влево Ø 5) с дегенеративным ядерным сдвигом Ø 6) с ядерным сдвигом вправо Ø
 Признаки дегенерации Ø Ø Ø Ø 1) токсогенная зернистость в цитоплазме нейтрофилов, образование которой связано с коагуляцией белков под действием инфекционного или токсического агента; 2) вакуолизация цитоплазмы и (реже) ядра - признак жировой дегенерации клетки, наиболее характерен для абсцессов, тяжелых форм сепсиса, лучевой болезни; 3) анизоцитоз лейкоцитов - появление микро- и гигантских форм клеток; 4) гипохроматоз - потеря ядром способности нормально окрашиваться, при этом оно может сохранять четкие контуры (хроматинолиз) либо не имеет их (кариолиз); 5) фрагментация - отшнуровка от ядра отдельных его фрагментов; 6) пикноз (уплотнение структуры хроматина) и рексис ядра - распад его на отдельные, не связанные между собой пикнотичные части; 7) гиперсегментация ядер нейтрофилов (при анемии Аддисона-Бирмера, лучевой болезни) и др.
Признаки дегенерации Ø Ø Ø Ø 1) токсогенная зернистость в цитоплазме нейтрофилов, образование которой связано с коагуляцией белков под действием инфекционного или токсического агента; 2) вакуолизация цитоплазмы и (реже) ядра - признак жировой дегенерации клетки, наиболее характерен для абсцессов, тяжелых форм сепсиса, лучевой болезни; 3) анизоцитоз лейкоцитов - появление микро- и гигантских форм клеток; 4) гипохроматоз - потеря ядром способности нормально окрашиваться, при этом оно может сохранять четкие контуры (хроматинолиз) либо не имеет их (кариолиз); 5) фрагментация - отшнуровка от ядра отдельных его фрагментов; 6) пикноз (уплотнение структуры хроматина) и рексис ядра - распад его на отдельные, не связанные между собой пикнотичные части; 7) гиперсегментация ядер нейтрофилов (при анемии Аддисона-Бирмера, лучевой болезни) и др.
 Дегенеративные изменения в лейкоцитах (по И. А. Кассирскому) А. Токсогенная зернистость нейтрофилов Б. Тельца Князькова. Деле (1) и зерна Амато (2) В. Вакуолизация нейтрофилов ( «простреленные» нейтрофилы) 6
Дегенеративные изменения в лейкоцитах (по И. А. Кассирскому) А. Токсогенная зернистость нейтрофилов Б. Тельца Князькова. Деле (1) и зерна Амато (2) В. Вакуолизация нейтрофилов ( «простреленные» нейтрофилы) 6
 Нейтропения обусловленная уменьшением образования нейтрофилов Чаще всего вызвана действием цитостатиков и иммунодепрессантов , - вызывают нейтропению за счет подавления пролиферации стволовых клеток в костном мозге. Некоторые антимикробные средства - могут вызвать нейтропению за счет подавления миелоидного ростка кроветворения. Повышенное разрушение клеток при разрушении их антителами (аутоиммунная нейтропения) препараты, которые, выступая в роли гаптенов, опосредуют разрушение нейтрофилов усиленное разрушение в печени и селезенке
Нейтропения обусловленная уменьшением образования нейтрофилов Чаще всего вызвана действием цитостатиков и иммунодепрессантов , - вызывают нейтропению за счет подавления пролиферации стволовых клеток в костном мозге. Некоторые антимикробные средства - могут вызвать нейтропению за счет подавления миелоидного ростка кроветворения. Повышенное разрушение клеток при разрушении их антителами (аутоиммунная нейтропения) препараты, которые, выступая в роли гаптенов, опосредуют разрушение нейтрофилов усиленное разрушение в печени и селезенке
 Агранулоцитоз – это клинико-гематологический синдром, характеризующийся резким снижением в крови количества гранулоцитов (менее 750 в одном кубическом миллиметре) и уменьшением общего количества лейкоцитов (менее 1000 в одном кубическом миллиметре). Различают две формы агранулоцитоза: - миелотоксический (при угнетении костного мозга некоторыми препаратами, в основном, - цитостатиками) - аутоиммунный (при ревматизме, системной красной волчанке и др. ) и так называемый «гаптеновый» , представляющий собой вариант аутоиммунного, но возникающий при массивном приёме некоторых лекарств (аспирина, амидопирина, бутадиона, барбитуратов и др. ). Пунктат костного мозга при агранулоцитозе. Полное отсутствие гранулоцитов. (по М. Г. Абрамову) 5
Агранулоцитоз – это клинико-гематологический синдром, характеризующийся резким снижением в крови количества гранулоцитов (менее 750 в одном кубическом миллиметре) и уменьшением общего количества лейкоцитов (менее 1000 в одном кубическом миллиметре). Различают две формы агранулоцитоза: - миелотоксический (при угнетении костного мозга некоторыми препаратами, в основном, - цитостатиками) - аутоиммунный (при ревматизме, системной красной волчанке и др. ) и так называемый «гаптеновый» , представляющий собой вариант аутоиммунного, но возникающий при массивном приёме некоторых лекарств (аспирина, амидопирина, бутадиона, барбитуратов и др. ). Пунктат костного мозга при агранулоцитозе. Полное отсутствие гранулоцитов. (по М. Г. Абрамову) 5
 Эозинофил
Эозинофил
 Эозинофилы человека обычно содержат двухдольчатое ядро и множество цитоплазматических гранул. Ø Эозинофилы осуществляют внеклеточное уничтожение крупных паразитических организмов. Ø Считается, что в норме эозинофилы угнетают воспаление. Ø Эозинофилия характерна для паразитарных инвазий и аллергических реакций Ø Эозинопения возникает при острой бактериальной инфекции , а также при стрессе Ø
Эозинофилы человека обычно содержат двухдольчатое ядро и множество цитоплазматических гранул. Ø Эозинофилы осуществляют внеклеточное уничтожение крупных паразитических организмов. Ø Считается, что в норме эозинофилы угнетают воспаление. Ø Эозинофилия характерна для паразитарных инвазий и аллергических реакций Ø Эозинопения возникает при острой бактериальной инфекции , а также при стрессе Ø
 Базофил
Базофил
 Моноцит
Моноцит
 Моноциты это лейкоциты , не содержащие гранул. Их диаметр в сухом мазке составляет 12 20 мкм. Ø Они обладают самой высокой способностью к фагоцитозу Ø Моноциты, выходя из кровяного русла, становятся макрофагами Ø Моноцитоз возникает при некоторых инфекциях: туберкулезе , бруцеллезе , а также при злокачественных опухолях , лейкозах , миелопролиферативных заболеваниях , гемолитической анемии. Ø Моноцитопения наблюдается при острой инфекции, апластической анемии и при стрессе Ø
Моноциты это лейкоциты , не содержащие гранул. Их диаметр в сухом мазке составляет 12 20 мкм. Ø Они обладают самой высокой способностью к фагоцитозу Ø Моноциты, выходя из кровяного русла, становятся макрофагами Ø Моноцитоз возникает при некоторых инфекциях: туберкулезе , бруцеллезе , а также при злокачественных опухолях , лейкозах , миелопролиферативных заболеваниях , гемолитической анемии. Ø Моноцитопения наблюдается при острой инфекции, апластической анемии и при стрессе Ø
 Лимфоциты
Лимфоциты
 Основная функция лимфоцитов реакции приобретенного (специфического) иммунитета. Ø Морфологически различают два типа циркулирующих лимфоцитов: относительно мелкие клетки, лишенных гранул и с высоким соотношением Я: Ц и более крупные клетки с меньшим содержанием Я: Ц и содержащие гранулы в цитоплазме, известные как большие гранулярные лимфоциты (БГЛ). Ø Существуют две популяции лимфоцитов: тимусзависимые ( T лимфоциты ) клеточный иммунитет , и независимые от тимуса ( B лимфоциты ), гуморальный иммунитет, которые функционируют совместно. Ø
Основная функция лимфоцитов реакции приобретенного (специфического) иммунитета. Ø Морфологически различают два типа циркулирующих лимфоцитов: относительно мелкие клетки, лишенных гранул и с высоким соотношением Я: Ц и более крупные клетки с меньшим содержанием Я: Ц и содержащие гранулы в цитоплазме, известные как большие гранулярные лимфоциты (БГЛ). Ø Существуют две популяции лимфоцитов: тимусзависимые ( T лимфоциты ) клеточный иммунитет , и независимые от тимуса ( B лимфоциты ), гуморальный иммунитет, которые функционируют совместно. Ø
 Локализация дифференцирующихся тимоцитов в различных областях тимуса. Пре Т клетки, мигрирующие из костного мозга в тимус, заселяют субкапсулярную зону тимуса. Клетки этой стадии развития представляют собой наименее зрелые формы, не экспрессирующие ТКР и относящиеся к категории двойных негативов (фенотип CD 4 CD 8 ТКР ). В результате их взаимодействия с эпителиальными клетками кормилицами, представленными в субкаспсуле, начинается процесс внутритимусной дифференцировки.
Локализация дифференцирующихся тимоцитов в различных областях тимуса. Пре Т клетки, мигрирующие из костного мозга в тимус, заселяют субкапсулярную зону тимуса. Клетки этой стадии развития представляют собой наименее зрелые формы, не экспрессирующие ТКР и относящиеся к категории двойных негативов (фенотип CD 4 CD 8 ТКР ). В результате их взаимодействия с эпителиальными клетками кормилицами, представленными в субкаспсуле, начинается процесс внутритимусной дифференцировки.
 Дифференцировка и селекция В-лимфоцитов
Дифференцировка и селекция В-лимфоцитов
 Ø Физиологический лимфоцитоз характерен для детей первых 10 лет жизни, а также отмечается у вегетарианцев и после физических нагрузок (миогенный). Ø Патологический лимфоцитоз - развивается при ряде инфекционных заболеваний (брюшной тиф, свинка, малярия, бруцеллез, туберкулез, сифилис и др. ), при алиментарной дистрофии, бронхиальной астме и некоторых эндокринных расстройствах
Ø Физиологический лимфоцитоз характерен для детей первых 10 лет жизни, а также отмечается у вегетарианцев и после физических нагрузок (миогенный). Ø Патологический лимфоцитоз - развивается при ряде инфекционных заболеваний (брюшной тиф, свинка, малярия, бруцеллез, туберкулез, сифилис и др. ), при алиментарной дистрофии, бронхиальной астме и некоторых эндокринных расстройствах
 «Лейкемоидные реакции» В гематологии выделяется особый тип патологических процессов, сходных по картине крови с лейкозами, но таковыми не являющимися. Они получили название лейкемоидных реакций. Лейкемоидные (подобные лейкозам) реакции - это патологичес- кие реакции крови, сходные с лейкемическими (сублейкемическими) картинами крови (миелоидными или лимфатическими), но отличные от них по патогенезу. Лейкемоидные реакции являются реактивными, в известной мере функциональными, состояниями кроветворного аппарата, возникающими в ответ на воздействие на организм какого-то повреждающего фактора (чаще всего инфекционного). Хотя у лейкемоидных реакций имеются черты сходства с лейкозами, однако, этиопатогенетической общности у этих двух процессов нет. Лейкоз - это самостоятельный патологический процесс, а лейкемоидная реакция - лишь симптом основного заболевания. Лейкоз - это неоплазия крови, лейкемоидная реакция, – фигурально выражаясь, “воспаление” крови. Дифференциальная диагностика лейкемоидных реакций с лейкозами чрезвычайно важна, поскольку методы их терапии (лечение основного заболевания) принципиально отличается от лечения лейкозов (воздействие прежде всего на систему кроветворения). В течении лейкемоидных реакций выделяют три фазы: выраженную лей- кемоидную реакцию; фазу спада лейкемоидной реакции; фазу нормализации со следовыми реакциями.
«Лейкемоидные реакции» В гематологии выделяется особый тип патологических процессов, сходных по картине крови с лейкозами, но таковыми не являющимися. Они получили название лейкемоидных реакций. Лейкемоидные (подобные лейкозам) реакции - это патологичес- кие реакции крови, сходные с лейкемическими (сублейкемическими) картинами крови (миелоидными или лимфатическими), но отличные от них по патогенезу. Лейкемоидные реакции являются реактивными, в известной мере функциональными, состояниями кроветворного аппарата, возникающими в ответ на воздействие на организм какого-то повреждающего фактора (чаще всего инфекционного). Хотя у лейкемоидных реакций имеются черты сходства с лейкозами, однако, этиопатогенетической общности у этих двух процессов нет. Лейкоз - это самостоятельный патологический процесс, а лейкемоидная реакция - лишь симптом основного заболевания. Лейкоз - это неоплазия крови, лейкемоидная реакция, – фигурально выражаясь, “воспаление” крови. Дифференциальная диагностика лейкемоидных реакций с лейкозами чрезвычайно важна, поскольку методы их терапии (лечение основного заболевания) принципиально отличается от лечения лейкозов (воздействие прежде всего на систему кроветворения). В течении лейкемоидных реакций выделяют три фазы: выраженную лей- кемоидную реакцию; фазу спада лейкемоидной реакции; фазу нормализации со следовыми реакциями.
 * Классификация лейкемоидных реакций миелоидного типа лейкемоидные реакции с картиной крови, соответствующей хроническому миелолейкозу лимфатического и моноцитарно-лимфатического типа монолимфатическая реакция (болезнь Филатова) эозинофильного типа На схеме представлены наиболее часто встречающиеся лейкемоидные реакции, однако, имеются и другие их типы. миелобластного типа
* Классификация лейкемоидных реакций миелоидного типа лейкемоидные реакции с картиной крови, соответствующей хроническому миелолейкозу лимфатического и моноцитарно-лимфатического типа монолимфатическая реакция (болезнь Филатова) эозинофильного типа На схеме представлены наиболее часто встречающиеся лейкемоидные реакции, однако, имеются и другие их типы. миелобластного типа
 Лейкемоидная реакция с картиной крови, соответствующей хроническому миелолейкозу (По И. А. Кассирскому) Лейкемоидные реакции, с картиной кро-ви, , соответствующей хроническому миело-лейкозу, развиваются при: - инфекциях: сепсисе, скарлатине, роже, гнойных процессах, дифтерии, крупозной пневмонии, туберкулезе, дизентерии, острой дистрофии печени при болезни Боткина и т. д. ; воздействии ионизирующей радиации; - шоке, травмах черепа; - интоксикациях (угарным газом, при уремии); метастазах в костный мозг злокачественных опухолей; - лимфогрануломатозе; при лечении кортикоидными гормонами. Картина крови при лейкемоидных реакци-ях этого типа напоминает таковую при хрони-ческом миелолейкозе: отмечается умеренный лейкоцитоз со сдвигом влево вплоть до про-миелоцитов.
Лейкемоидная реакция с картиной крови, соответствующей хроническому миелолейкозу (По И. А. Кассирскому) Лейкемоидные реакции, с картиной кро-ви, , соответствующей хроническому миело-лейкозу, развиваются при: - инфекциях: сепсисе, скарлатине, роже, гнойных процессах, дифтерии, крупозной пневмонии, туберкулезе, дизентерии, острой дистрофии печени при болезни Боткина и т. д. ; воздействии ионизирующей радиации; - шоке, травмах черепа; - интоксикациях (угарным газом, при уремии); метастазах в костный мозг злокачественных опухолей; - лимфогрануломатозе; при лечении кортикоидными гормонами. Картина крови при лейкемоидных реакци-ях этого типа напоминает таковую при хрони-ческом миелолейкозе: отмечается умеренный лейкоцитоз со сдвигом влево вплоть до про-миелоцитов.
 Лейкемоидные реакции эозинофильного типа (по И. А. Кассирскому) Данные реакции развиваются в основ-ном либо при аллергических процессах, либо при заболеваниях, которые имеют выраженный аллергический компонент. В крови большое количество эозинофилов (до 90% при лейкоцитозе около 100 000), как правило, при отсутствии эозинофильного сдвига влево. Нередко наблюдается гиперсегментация ядер эозинофилов. Препарат: мазок крови при эозинофильном коллагенозе.
Лейкемоидные реакции эозинофильного типа (по И. А. Кассирскому) Данные реакции развиваются в основ-ном либо при аллергических процессах, либо при заболеваниях, которые имеют выраженный аллергический компонент. В крови большое количество эозинофилов (до 90% при лейкоцитозе около 100 000), как правило, при отсутствии эозинофильного сдвига влево. Нередко наблюдается гиперсегментация ядер эозинофилов. Препарат: мазок крови при эозинофильном коллагенозе.
 Лейкемоидные реакции миелобластного типа (по И. А. Кассирскому) Это самый трудный для дифференциальной диагностики с лейкозами тип лейкемоидных реакций, поскольку при нем омоложение крови идет до миелобластов. Такие реакции развиваются при сепсисе, туберкулезе и метастазах злокачественных опухолей в костный мозг. Препарат: картина крови при лейкемоидной реакции миелобластного типа. Омоложение крови вплоть до появления миелобластов.
Лейкемоидные реакции миелобластного типа (по И. А. Кассирскому) Это самый трудный для дифференциальной диагностики с лейкозами тип лейкемоидных реакций, поскольку при нем омоложение крови идет до миелобластов. Такие реакции развиваются при сепсисе, туберкулезе и метастазах злокачественных опухолей в костный мозг. Препарат: картина крови при лейкемоидной реакции миелобластного типа. Омоложение крови вплоть до появления миелобластов.
 Инфекционный мононуклеоз (болезнь Филатова). По И. А. Кассирскому Это заболевание впервые описано в 1885 году Н. Ф. Филатовым. Для картины крови характерны : обилие лимфоцитов (50 - 70%) [1], высокое содержание моноцитов (10 - 12% в начале и до 40 - 50% в разгаре болезни) [2] и появление лимфоидно – ретикулярных клеток Отмечается умеренный лейкоцитоз, максимально достигающий в отдельных случаях 20 000 - 25 000. Анемии, как правило, не наблюдается, число тромбоцитов - обычно нормально, иногда снижается до 100 000 - 80 000.
Инфекционный мононуклеоз (болезнь Филатова). По И. А. Кассирскому Это заболевание впервые описано в 1885 году Н. Ф. Филатовым. Для картины крови характерны : обилие лимфоцитов (50 - 70%) [1], высокое содержание моноцитов (10 - 12% в начале и до 40 - 50% в разгаре болезни) [2] и появление лимфоидно – ретикулярных клеток Отмечается умеренный лейкоцитоз, максимально достигающий в отдельных случаях 20 000 - 25 000. Анемии, как правило, не наблюдается, число тромбоцитов - обычно нормально, иногда снижается до 100 000 - 80 000.
 Лейкозы (лейкемии) – системные опухолевые заболевания кроветворной ткани
Лейкозы (лейкемии) – системные опухолевые заболевания кроветворной ткани
 Критерии идентификации лейкозов Наличие и характер отклонений в генотипе Ø Изменение иммунного фенотипа клеток Ø Морфологические особенности клеток Ø Структурные и гистохимические отличия клеток Ø Наличие и количество незрелых и бластных лейкозных клеток в крови Ø Особенности клинического течения лейкоза Ø
Критерии идентификации лейкозов Наличие и характер отклонений в генотипе Ø Изменение иммунного фенотипа клеток Ø Морфологические особенности клеток Ø Структурные и гистохимические отличия клеток Ø Наличие и количество незрелых и бластных лейкозных клеток в крови Ø Особенности клинического течения лейкоза Ø
 По клиническому течению: Острые лейкозы (лейкемии) – начинаются остро, быстро прогрессируют, при отсутствии лечения приводят к смерти в течение нескольких месяцев. В крови обычно определяется большое количество бластных клеток. Хронические лейкозы (лейкемии) начинаются постепенно и медленно прогрессируют, даже при отсутствии лечения больные могут прожить несколько лет. В крови выявляются обычно незрелые, но с тенденцией к созреванию клетки.
По клиническому течению: Острые лейкозы (лейкемии) – начинаются остро, быстро прогрессируют, при отсутствии лечения приводят к смерти в течение нескольких месяцев. В крови обычно определяется большое количество бластных клеток. Хронические лейкозы (лейкемии) начинаются постепенно и медленно прогрессируют, даже при отсутствии лечения больные могут прожить несколько лет. В крови выявляются обычно незрелые, но с тенденцией к созреванию клетки.
 По картине периферический крови: Ø Ø Лейкемические, которые характеризуются значительным увеличением количества лейкоцитов, в том числе и лейкозных клеток, в периферической крови (десятки и сотни тысяч, иногда до миллиона в 1 мкл крови). Это наиболее частая форма. Сублейкемические, при которых количество лейкоцитов несколько выше нормы (15 25 тысяч в 1 мкл крови), но в крови определяются опухолевые клетки. Алейкемические, при которых количество лейкоцитов в пределах нормы, в крови не определяются опухолевые клетки. Этот тип наблюдается редко, но он возникает обычно уже на ранних этапах заболевания. С целью диагностики используют трепанобиопсию крыла подвздошной кости или пунктат костного мозга грудины. Лейкопенические, при которых количество лейкоцитов ниже нормы, иногда может достигать одной тысячи, но могут быть качественные изменения, обусловленные появлением лейкозных клеток.
По картине периферический крови: Ø Ø Лейкемические, которые характеризуются значительным увеличением количества лейкоцитов, в том числе и лейкозных клеток, в периферической крови (десятки и сотни тысяч, иногда до миллиона в 1 мкл крови). Это наиболее частая форма. Сублейкемические, при которых количество лейкоцитов несколько выше нормы (15 25 тысяч в 1 мкл крови), но в крови определяются опухолевые клетки. Алейкемические, при которых количество лейкоцитов в пределах нормы, в крови не определяются опухолевые клетки. Этот тип наблюдается редко, но он возникает обычно уже на ранних этапах заболевания. С целью диагностики используют трепанобиопсию крыла подвздошной кости или пунктат костного мозга грудины. Лейкопенические, при которых количество лейкоцитов ниже нормы, иногда может достигать одной тысячи, но могут быть качественные изменения, обусловленные появлением лейкозных клеток.
 Эпидемиология. Ежегодно регистрируется 35 случаев острых лейкозов на 1 млн населения. Встречаемость которых зависит от возраста. Так в группе до 15 лет соотношение ОЛЛ: ОМЛ составляет 4: 1, в группе от 15 до 35 лет - 1: 1. 5, а в возрастной группе старше 35 лет -1: 8. Мужчины и женщины болеют с одинаковой частотой.
Эпидемиология. Ежегодно регистрируется 35 случаев острых лейкозов на 1 млн населения. Встречаемость которых зависит от возраста. Так в группе до 15 лет соотношение ОЛЛ: ОМЛ составляет 4: 1, в группе от 15 до 35 лет - 1: 1. 5, а в возрастной группе старше 35 лет -1: 8. Мужчины и женщины болеют с одинаковой частотой.
 Группу острых лейкозов объединяет общий морфологический признак: субстрат опухоли представлен незрелыми молодыми клетками - бластами.
Группу острых лейкозов объединяет общий морфологический признак: субстрат опухоли представлен незрелыми молодыми клетками - бластами.
 Под термином "острые лейкозы" понимают группу клональных заболеваний, первично возникающих в костном мозге в результате мутации стволовой клетки крови. Следствием мутации является потеря потомками мутировавшей клетки способности к дифференцировке до зрелых клеток крови.
Под термином "острые лейкозы" понимают группу клональных заболеваний, первично возникающих в костном мозге в результате мутации стволовой клетки крови. Следствием мутации является потеря потомками мутировавшей клетки способности к дифференцировке до зрелых клеток крови.
 Наследственность Синдром Дауна , синдром Клайнфельтера и синдром Патау , предрасполагают к развитию ОМЛ. Ø Заболеваемость ОМЛ возрастает при анемии Фанкони , атаксии телеангиэктазии , синдроме Костмана и синдроме Блума.
Наследственность Синдром Дауна , синдром Клайнфельтера и синдром Патау , предрасполагают к развитию ОМЛ. Ø Заболеваемость ОМЛ возрастает при анемии Фанкони , атаксии телеангиэктазии , синдроме Костмана и синдроме Блума.
 Ионизирующее излучение
Ионизирующее излучение
 Химические средства Воздействие бензола курение работа с нефтепродуктами, красителями , этиленоксидом , гербицидами , пестицидами , формальдегидом и другими фиксирующими жидкостями Ø воздействие электромагнитного излучения. Ø Ø Ø
Химические средства Воздействие бензола курение работа с нефтепродуктами, красителями , этиленоксидом , гербицидами , пестицидами , формальдегидом и другими фиксирующими жидкостями Ø воздействие электромагнитного излучения. Ø Ø Ø
 Лекарственные преараты После лечения алкилирующими средствами лейкозы развиваются в среднем через 48 72 мес и характеризуются аберрациями 5 й и 7 й хромосом. Ø Лейкозы, вызванные применением ингибиторов ДНК топоизомеразы II , возникают через 1 3 года после лечения и обычно сопровождаются повреждением длинного плеча 11 й хромосомы (сегмент Hq 23). Ø хлорамфеникол , фенилбутазон и, реже, хлорохин и метоксален вызывают аплазию костного мозга с исходом в острый миелоидный лейкоз. Ø
Лекарственные преараты После лечения алкилирующими средствами лейкозы развиваются в среднем через 48 72 мес и характеризуются аберрациями 5 й и 7 й хромосом. Ø Лейкозы, вызванные применением ингибиторов ДНК топоизомеразы II , возникают через 1 3 года после лечения и обычно сопровождаются повреждением длинного плеча 11 й хромосомы (сегмент Hq 23). Ø хлорамфеникол , фенилбутазон и, реже, хлорохин и метоксален вызывают аплазию костного мозга с исходом в острый миелоидный лейкоз. Ø
 Признаки острых лейкозов Недостаточность костного мозга Ø Анемия Ø Снижение резистентности к инфекциям Ø Геморрагический синдром Ø ДВС синдром Ø Интоксикация Ø Гепатоспленомегалия Ø Болезненность костей Ø Лимфаденопатии Ø Нейролейкемия Ø
Признаки острых лейкозов Недостаточность костного мозга Ø Анемия Ø Снижение резистентности к инфекциям Ø Геморрагический синдром Ø ДВС синдром Ø Интоксикация Ø Гепатоспленомегалия Ø Болезненность костей Ø Лимфаденопатии Ø Нейролейкемия Ø
 Течение Терминальная В течение ОМЛ выделяется 5 стадий: характеризуется Начальная резистентностью к цитостатической терапии, угнетением норм. кроветворения, развитием язвеннонекротических процессов. Рецидив диагностирует Развернутая Ремиссия Развернутая ся, когда у характеризуется (полная или Может возникать в костном больных с неполная) мозге или вне костного мозга неполная) предшествую наличием (кожа и т. д. ). щей анемией в основных дальнейшем клинических и К полной относится состояния, при котором гематологически развивается х проявлений отсутствуют клинические симптомы заболевания картина При неполной ремиссии имеет место заболевания острого отчетливое клиническое и гематологическое лейкоза. улучшение
Течение Терминальная В течение ОМЛ выделяется 5 стадий: характеризуется Начальная резистентностью к цитостатической терапии, угнетением норм. кроветворения, развитием язвеннонекротических процессов. Рецидив диагностирует Развернутая Ремиссия Развернутая ся, когда у характеризуется (полная или Может возникать в костном больных с неполная) мозге или вне костного мозга неполная) предшествую наличием (кожа и т. д. ). щей анемией в основных дальнейшем клинических и К полной относится состояния, при котором гематологически развивается х проявлений отсутствуют клинические симптомы заболевания картина При неполной ремиссии имеет место заболевания острого отчетливое клиническое и гематологическое лейкоза. улучшение
 Острая миелобластная лейкемия (ОМЛ) Ø M 1 Состоит только из миелобластов без созревания Ø M 2 Миелобласты с признаками созревания Ø M 3 Острая промиелобластная лейкемия; промиелобласты имеют множество темных азурофильных цитоплазматических гранул. Ø M 4 Острая миеломонобластная лейкемия, развивающаяся из общих клеток предшественников моноцитов и гранулоцитов. Ø M 5 Острая монобластная лейкемия Ø M 6 Эритролейкемия (синдром Ди Гуглиельмо; доминируют эритробласты присутствии миелобластов. Ø M 7 Мегакариобластная лейкемия
Острая миелобластная лейкемия (ОМЛ) Ø M 1 Состоит только из миелобластов без созревания Ø M 2 Миелобласты с признаками созревания Ø M 3 Острая промиелобластная лейкемия; промиелобласты имеют множество темных азурофильных цитоплазматических гранул. Ø M 4 Острая миеломонобластная лейкемия, развивающаяся из общих клеток предшественников моноцитов и гранулоцитов. Ø M 5 Острая монобластная лейкемия Ø M 6 Эритролейкемия (синдром Ди Гуглиельмо; доминируют эритробласты присутствии миелобластов. Ø M 7 Мегакариобластная лейкемия

 Терапия ОМЛ В настоящее время основным методом лечения острых лейкозов является полихимиотерапия Важной составляющей современной терапии ОМЛ является трансплантация ГСК. Источником ГСК служит костный мозг или периферическая кровь. При ОМЛ применяют аллогенную трансплантацию ГСК от родственного или неродственного донора и аутологичную трансплантацию (трансплантация собственных ГСК при отсутствии поражения костного мозга, т. е. в периоде ремиссии).
Терапия ОМЛ В настоящее время основным методом лечения острых лейкозов является полихимиотерапия Важной составляющей современной терапии ОМЛ является трансплантация ГСК. Источником ГСК служит костный мозг или периферическая кровь. При ОМЛ применяют аллогенную трансплантацию ГСК от родственного или неродственного донора и аутологичную трансплантацию (трансплантация собственных ГСК при отсутствии поражения костного мозга, т. е. в периоде ремиссии).
 Острая лимфобластная лейкемия (острый лимфолейкоз) – злокачественное заболевание, возникающее в результате клональной пролиферации незрелых лимфоидных клеток
Острая лимфобластная лейкемия (острый лимфолейкоз) – злокачественное заболевание, возникающее в результате клональной пролиферации незрелых лимфоидных клеток
 Классификация острого лимфолейкоза Морфологическая классификация острого лимфобластного лейкоза согласно Fаb классификации включает три группы: 1) L 1 клетка: типичные микролимфобласты, высокое ядерно цитоплазматическое отношение, ядро правильной формы, имеет дефект хромосом t(9, 22)(q 34. 1; q 11. 2). В 75 80% случаев характерен для детей. 2) L 2 клетка: большие лимфобласты с отчетливыми ядрышками неправильной формы, имеет хромосомный дефект – t(4; 11)(q 21; q 23). Встречается в 20% случаев, типична для взрослых. 3) L 3 клетка: большие, однородные, ядро с выраженными нуклеолами, имеет дефект хромосом t(8, 14)(q 24. 1; q 32. 3). встречается как у взрослых, так и у детей, около 5 % случаев. Иммунологическая классификация: ОЛЛ В клеточной линии ОЛЛ Т клеточной линии ОЛЛ недифференциируемый (ни Т, ни В)
Классификация острого лимфолейкоза Морфологическая классификация острого лимфобластного лейкоза согласно Fаb классификации включает три группы: 1) L 1 клетка: типичные микролимфобласты, высокое ядерно цитоплазматическое отношение, ядро правильной формы, имеет дефект хромосом t(9, 22)(q 34. 1; q 11. 2). В 75 80% случаев характерен для детей. 2) L 2 клетка: большие лимфобласты с отчетливыми ядрышками неправильной формы, имеет хромосомный дефект – t(4; 11)(q 21; q 23). Встречается в 20% случаев, типична для взрослых. 3) L 3 клетка: большие, однородные, ядро с выраженными нуклеолами, имеет дефект хромосом t(8, 14)(q 24. 1; q 32. 3). встречается как у взрослых, так и у детей, около 5 % случаев. Иммунологическая классификация: ОЛЛ В клеточной линии ОЛЛ Т клеточной линии ОЛЛ недифференциируемый (ни Т, ни В)
 Классификация острых лимфобластных лейкозов Вариант по Частот Хромосомные классификации Иммунофенотип а, % аберрации FAB Пре-Влимфобластный 75 лейкоз L 1, L 2 t(9; 22), t(4; 11), t(1; 19) Тлимфобластный 20 лейкоз LI, L 2 Мутации в сегментах 14 q 11 или 7 q 34 Влимфобластный 5 лейкоз L 3 t(8; 14), t(8; 22), t(2; 8)
Классификация острых лимфобластных лейкозов Вариант по Частот Хромосомные классификации Иммунофенотип а, % аберрации FAB Пре-Влимфобластный 75 лейкоз L 1, L 2 t(9; 22), t(4; 11), t(1; 19) Тлимфобластный 20 лейкоз LI, L 2 Мутации в сегментах 14 q 11 или 7 q 34 Влимфобластный 5 лейкоз L 3 t(8; 14), t(8; 22), t(2; 8)
 Классификация лимфолейкозов по антигенным маркерам BПре-B клеточны ОЛЛ й ОЛЛ Tклеточны й ОЛЛ Хронический лимфолейкоз Антиген, специфичный для лимфоидных предшественников и пре-B + -клеток (CALLA) + - - - Цитоплазматические цепи мю - + - - - Поверхностные цепи мю - - + Поверхностные цепи каппа+лямбда - - - Td. T + + - CD 5(T 1) - - - + + CD 2(T 11) - - - + - HLA-DR + + + - + Маркер лимфоцитов Сокращения: ОЛЛ - острый лимфобластный лейкоз ; CALLA - common acute lymphoblastic leukaemia antigen; Td. T - терминальная дезоксинуклеотидилтрансфераза. О Л Л
Классификация лимфолейкозов по антигенным маркерам BПре-B клеточны ОЛЛ й ОЛЛ Tклеточны й ОЛЛ Хронический лимфолейкоз Антиген, специфичный для лимфоидных предшественников и пре-B + -клеток (CALLA) + - - - Цитоплазматические цепи мю - + - - - Поверхностные цепи мю - - + Поверхностные цепи каппа+лямбда - - - Td. T + + - CD 5(T 1) - - - + + CD 2(T 11) - - - + - HLA-DR + + + - + Маркер лимфоцитов Сокращения: ОЛЛ - острый лимфобластный лейкоз ; CALLA - common acute lymphoblastic leukaemia antigen; Td. T - терминальная дезоксинуклеотидилтрансфераза. О Л Л
 Симптомы острого лимфолейкоза: Ø Ø Ø Ø очень высокая t тела общая слабость и усталость озноб отсутствие аппетита носовые кровотечения кровоточивость слизистой оболочки полости рта язвенный стоматит, некротическая ангина увеличение шейных, поднижнечелюстных лимфатических узлов подкожно жировая клетчатка в области шеи отечна желудочные кровотечения возможна спленомегалия прогрессирующая анемия, тромбоцитопения сильные боли в костях бактериальные и грибковые инфекции
Симптомы острого лимфолейкоза: Ø Ø Ø Ø очень высокая t тела общая слабость и усталость озноб отсутствие аппетита носовые кровотечения кровоточивость слизистой оболочки полости рта язвенный стоматит, некротическая ангина увеличение шейных, поднижнечелюстных лимфатических узлов подкожно жировая клетчатка в области шеи отечна желудочные кровотечения возможна спленомегалия прогрессирующая анемия, тромбоцитопения сильные боли в костях бактериальные и грибковые инфекции

 Лечение острых лейкозов Химиотерапия Ø Сопутствующая терапия Ø Заместительная терапия Ø Трансплантация Ø
Лечение острых лейкозов Химиотерапия Ø Сопутствующая терапия Ø Заместительная терапия Ø Трансплантация Ø
 Цитохимическая идентификация острых лейкемий Тип Лимфобластная 1 Перокси даза – Суда Хлороаце н татчерн эстераза ый – – ШИ Неспецифиче Kская эстераза реак ция – Морфологиче ские признаки + Единственное ядрышко Миелобластная + + + – – Множественн ые ядрышки, палочки Ауэра Моноцитарная – – – + – – Миеломоноцитарн ая + + – – Неклассифицирова нная – – –
Цитохимическая идентификация острых лейкемий Тип Лимфобластная 1 Перокси даза – Суда Хлороаце н татчерн эстераза ый – – ШИ Неспецифиче Kская эстераза реак ция – Морфологиче ские признаки + Единственное ядрышко Миелобластная + + + – – Множественн ые ядрышки, палочки Ауэра Моноцитарная – – – + – – Миеломоноцитарн ая + + – – Неклассифицирова нная – – –
 Положительная реакция на МПО (миелопероксидаза образует гипохлорит анион, который, будучи сильным окислителем, обладает неспецифическим бактерицидным действием) в бластах (М 3) (костный мозг) Положительная реакция на МПО в нейтрофилах и отрицательная в бластах при ОЛЛ (L 2).
Положительная реакция на МПО (миелопероксидаза образует гипохлорит анион, который, будучи сильным окислителем, обладает неспецифическим бактерицидным действием) в бластах (М 3) (костный мозг) Положительная реакция на МПО в нейтрофилах и отрицательная в бластах при ОЛЛ (L 2).
 Положительная реакция на липиды (обнаруживаются практически во всех лейкоцитах, за исключением лимфоцитов) в нейтрофилах и отрицательная в лимфоците. Положительная реакция на липиды в бластах (М 2).
Положительная реакция на липиды (обнаруживаются практически во всех лейкоцитах, за исключением лимфоцитов) в нейтрофилах и отрицательная в лимфоците. Положительная реакция на липиды в бластах (М 2).
 Положительная реакция на неспецифическую эстеразу в бластах (костный мозг) – о. миеломонобластный лейкоз (М 4). Частичное подавление неспецифической эстеразы в бластах фторидом натрия (костный мозг) – о. миеломонобластный лейкоз (М 4) Определение активности неспецифической эстеразы используется для идентификации лейкозных моноцитарных предшественников. Эти клетки, как правило, проявляют высокую активность неспецифической эстеразы с субстратами бутират, ацетат и AS D ацетат, которая в значительной степени ингибируется фторидом натрия. .
Положительная реакция на неспецифическую эстеразу в бластах (костный мозг) – о. миеломонобластный лейкоз (М 4). Частичное подавление неспецифической эстеразы в бластах фторидом натрия (костный мозг) – о. миеломонобластный лейкоз (М 4) Определение активности неспецифической эстеразы используется для идентификации лейкозных моноцитарных предшественников. Эти клетки, как правило, проявляют высокую активность неспецифической эстеразы с субстратами бутират, ацетат и AS D ацетат, которая в значительной степени ингибируется фторидом натрия. .
 Хронический миелолейкоз Опухолевое заболевание при котором субстратом опухоли служат морфологически зрелые клетки миелоидного ряда являющиеся потомками единственной стволовой клетки, как правило (в 98%), несущей реципрокную транслокацию между длинными плечами 9 й и 22 й хромосом.
Хронический миелолейкоз Опухолевое заболевание при котором субстратом опухоли служат морфологически зрелые клетки миелоидного ряда являющиеся потомками единственной стволовой клетки, как правило (в 98%), несущей реципрокную транслокацию между длинными плечами 9 й и 22 й хромосом.

 Экспрессия химерного белка p 210 BCR/ABL приводит к: а) увеличение стимуляции пролиферации и подавляет апоптоза, а также увеличение синтеза интегринов , обеспечивающим лучшее прикрепление к внеклеточному матриксу б)инактивации апоптогенных активностей Abl
Экспрессия химерного белка p 210 BCR/ABL приводит к: а) увеличение стимуляции пролиферации и подавляет апоптоза, а также увеличение синтеза интегринов , обеспечивающим лучшее прикрепление к внеклеточному матриксу б)инактивации апоптогенных активностей Abl
 Проявления ХМЛ В развернутую стадию: как правило, развивается незаметно, поэтому у многих больных его выявляют случайно, в ходе профилактического осмотра. Ø Терминальная стадии слабость, утомляемость , похудание , спленомегалиея, частые инфекции , тромбозы или кровоточивость , обусловленные нарушением функции нейтрофилов и тромбоцитов. Ø
Проявления ХМЛ В развернутую стадию: как правило, развивается незаметно, поэтому у многих больных его выявляют случайно, в ходе профилактического осмотра. Ø Терминальная стадии слабость, утомляемость , похудание , спленомегалиея, частые инфекции , тромбозы или кровоточивость , обусловленные нарушением функции нейтрофилов и тромбоцитов. Ø
 Хронический лимфолейкоз (ХЛЛ) Опухоль иммунокомпетентной ткани, состоящая преимущественно из зрелых лимфоцитов, представленных в большинстве случаев CD 5+ -позитивными В-клетками (95% случаев) и Тлимфоцитами.
Хронический лимфолейкоз (ХЛЛ) Опухоль иммунокомпетентной ткани, состоящая преимущественно из зрелых лимфоцитов, представленных в большинстве случаев CD 5+ -позитивными В-клетками (95% случаев) и Тлимфоцитами.
 Патогенез Мутация клетки Лимфоидная пролиферация Угнетение нормального кроветворения Анемия + тромбоцитопения Диссеминация в лимфоузлы, печень селезёнку. Лимфоцитарный лейкоцитоз
Патогенез Мутация клетки Лимфоидная пролиферация Угнетение нормального кроветворения Анемия + тромбоцитопения Диссеминация в лимфоузлы, печень селезёнку. Лимфоцитарный лейкоцитоз
 Стадии хронического лимфолейкоза Стадия Признаки Выживаемость, годы Классификация Реяа 0 Лимфоцитоз 12 I Лимфоцитоз + увеличение лимфоузлов 9 II Лимфоцитоз + спленомегалия 7 III Анемия 1— 2 IV Тромбоцитопения 1— 2 Классификация Винеб А Анемии и тромбоцитопении нет, поражено менее > 10 трех анатомических зон В Анемии и тромбоцитопении нет, поражены три 5 анатомические зоны или более С Анемия или тромбоцитопения 2
Стадии хронического лимфолейкоза Стадия Признаки Выживаемость, годы Классификация Реяа 0 Лимфоцитоз 12 I Лимфоцитоз + увеличение лимфоузлов 9 II Лимфоцитоз + спленомегалия 7 III Анемия 1— 2 IV Тромбоцитопения 1— 2 Классификация Винеб А Анемии и тромбоцитопении нет, поражено менее > 10 трех анатомических зон В Анемии и тромбоцитопении нет, поражены три 5 анатомические зоны или более С Анемия или тромбоцитопения 2
 Симптомы Ø Ø Ø Ø Ø общая слабость, снижение трудоспособности; повышение температуры тела; тяжесть в левом подреберье; головокружения, потливость; похудание; носовые, десневые, маточные кровотечения; кровоизлияния в кожу и слизистые оболочки; частые простудные заболевания; увеличение лимфоузлов.
Симптомы Ø Ø Ø Ø Ø общая слабость, снижение трудоспособности; повышение температуры тела; тяжесть в левом подреберье; головокружения, потливость; похудание; носовые, десневые, маточные кровотечения; кровоизлияния в кожу и слизистые оболочки; частые простудные заболевания; увеличение лимфоузлов.

 Диагностика Общий анализ крови и микроскопия Лейкоцитоз, абсолютный лимфоцитоз. Количество лимфоцитов может достигать 600· 10^9/л. Лимфоциты малые, округлой формы, цитоплазма узкая, слабобазофильная, хроматин крупноглыбчатый. Характерные признаки - тени Боткина-Гумпрехта, нормоцитарная нормохромная анемия, ретикулоцитоз, тромбоцитопения. Иммунофенотипирование Помимо Аг В-лимфоцитов (СD 79 a, CD 19, CD 20, CD 22), опухолевые клетки при ХЛЛ экспрессируют Аг CD 5 и CD 23, слабо экспрессируют Ig. M, s. Ig. D+/-. Иммунохимический анализ крови, мочи ■ снижение всех классов Ig ■ наличие моноклонального Ig. M
Диагностика Общий анализ крови и микроскопия Лейкоцитоз, абсолютный лимфоцитоз. Количество лимфоцитов может достигать 600· 10^9/л. Лимфоциты малые, округлой формы, цитоплазма узкая, слабобазофильная, хроматин крупноглыбчатый. Характерные признаки - тени Боткина-Гумпрехта, нормоцитарная нормохромная анемия, ретикулоцитоз, тромбоцитопения. Иммунофенотипирование Помимо Аг В-лимфоцитов (СD 79 a, CD 19, CD 20, CD 22), опухолевые клетки при ХЛЛ экспрессируют Аг CD 5 и CD 23, слабо экспрессируют Ig. M, s. Ig. D+/-. Иммунохимический анализ крови, мочи ■ снижение всех классов Ig ■ наличие моноклонального Ig. M
 Пункция костного мозга ■ Лимфоцитоз вплоть до тотальной метаплазии ■ Расширение территории красного ростка ■ Парциальная красно-клеточная аплазия ПЦР Цитогенетический анализ ■ трисомия 12 ■ делеция 11 q, 13 q, 14 q, 6 q, 16 p. Серологические исследования ■ при аутоиммунном гемолизе – положительная проба Кумбса, наличие антиэритроцитарных Ig. G на эритроцитах ■ при тромбоцитопении наличие антитромбоцитарных АТ.
Пункция костного мозга ■ Лимфоцитоз вплоть до тотальной метаплазии ■ Расширение территории красного ростка ■ Парциальная красно-клеточная аплазия ПЦР Цитогенетический анализ ■ трисомия 12 ■ делеция 11 q, 13 q, 14 q, 6 q, 16 p. Серологические исследования ■ при аутоиммунном гемолизе – положительная проба Кумбса, наличие антиэритроцитарных Ig. G на эритроцитах ■ при тромбоцитопении наличие антитромбоцитарных АТ.
 Лечение Ø Специфическая химиотерапия Ø Лучевую терапию, Ø Спленэктомию Ø Сопроводительную терапию
Лечение Ø Специфическая химиотерапия Ø Лучевую терапию, Ø Спленэктомию Ø Сопроводительную терапию


